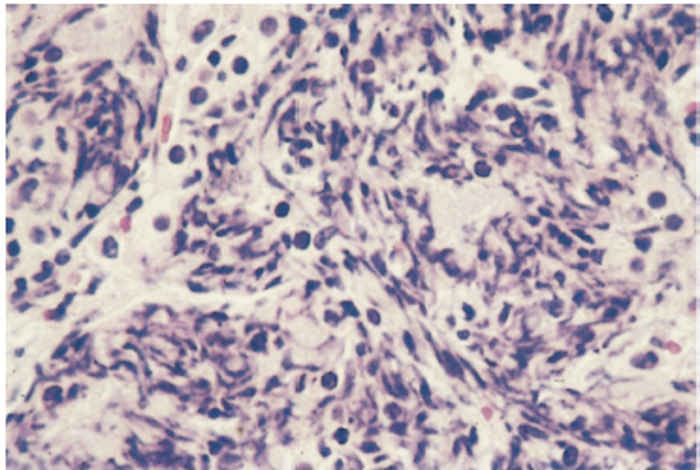

- Infectious Diseases of Livestock
- Part 3
- Pneumonic mannheimiosis and pasteurellosis of cattle
- GENERAL INTRODUCTION: SPIROCHAETES
- Swine dysentery
- Borrelia theileri infection
- Borrelia suilla infection
- Lyme disease in livestock
- Leptospirosis
- GENERAL INTRODUCTION: AEROBIC ⁄ MICRO-AEROPHILIC, MOTILE, HELICAL ⁄ VIBROID GRAM-NEGATIVE BACTERIA
- Genital campylobacteriosis in cattle
- Proliferative enteropathies of pigs
- Campylobacter jejuni infection
- GENERAL INTRODUCTION: GRAM-NEGATIVE AEROBIC OR CAPNOPHILIC RODS AND COCCI
- Moraxella spp. infections
- Bordetella bronchiseptica infections
- Pseudomonas spp. infections
- Glanders
- Melioidosis
- Brucella spp. infections
- Bovine brucellosis
- Brucella ovis infection
- Brucella melitensis infection
- Brucella suis infection
- Brucella infections in terrestrial wildlife
- GENERAL INTRODUCTION: FACULTATIVELY ANAEROBIC GRAM NEGATIVE RODS
- Klebsiella spp. infections
- Escherichia coli infections
- Salmonella spp. infections
- Bovine salmonellosis
- Ovine and caprine salmonellosis
- Porcine salmonellosis
- Equine salmonellosis
- Yersinia spp. infections
- Haemophilus and Histophilus spp. infections
- Haemophilus parasuis infection
- Histophilus somni disease complex in cattle
- Actinobacillus spp. infections
- infections
- Actinobacillus equuli infections
- Gram-negative pleomorphic infections: Actinobacillus seminis, Histophilus ovis and Histophilus somni
- Porcine pleuropneumonia
- Actinobacillus suis infections
- Pasteurella and Mannheimia spp. infections
- Pneumonic mannheimiosis and pasteurellosis of cattle
- Haemorrhagic septicaemia
- Pasteurellosis in sheep and goats
- Porcine pasteurellosis
- Progressive atrophic rhinitis
- GENERAL INTRODUCTION: ANAEROBIC GRAM-NEGATIVE, IRREGULAR RODS
- Fusobacterium necrophorum, Dichelobacter (Bacteroides) nodosus and Bacteroides spp. infections
- GENERAL INTRODUCTION: GRAM-POSITIVE COCCI
- Staphylococcus spp. infections
- Staphylococcus aureus infections
- Exudative epidermitis
- Other Staphylococcus spp. infections
- Streptococcus spp. infections
- Strangles
- Streptococcus suis infections
- Streptococcus porcinus infections
- Other Streptococcus spp. infections
- GENERAL INTRODUCTION: ENDOSPORE-FORMING GRAM-POSITIVE RODS AND COCCI
- Anthrax
- Clostridium perfringens group infections
- Clostridium perfringens type A infections
- Clostridium perfringens type B infections
- Clostridium perfringens type C infections
- Clostridium perfringens type D infections
- Malignant oedema⁄gas gangrene group of Clostridium spp.
- Clostridium chauvoei infections
- Clostridium novyi infections
- Clostridium septicum infections
- Other clostridial infections
- Tetanus
- Botulism
- GENERAL INTRODUCTION: REGULAR, NON-SPORING, GRAM-POSITIVE RODS
- Listeriosis
- Erysipelothrix rhusiopathiae infections
- GENERAL INTRODUCTION: IRREGULAR, NON-SPORING, GRAM-POSITIVE RODS
- Corynebacterium pseudotuberculosis infections
- Corynebacterium renale group infections
- Bolo disease
- Actinomyces bovis infections
- Trueperella pyogenes infections
- Actinobaculum suis infections
- Actinomyces hyovaginalis infections
- GENERAL INTRODUCTION: MYCOBACTERIA
- Tuberculosis
- Paratuberculosis
- GENERAL INTRODUCTION: ACTINOMYCETES
- Nocardiosis
- Rhodococcus equi infections
- Dermatophilosis
- GENERAL INTRODUCTION: MOLLICUTES
- Contagious bovine pleuropneumonia
- Contagious caprine pleuropneumonia
- Mycoplasmal pneumonia of pigs
- Mycoplasmal polyserositis and arthritis of pigs
- Mycoplasmal arthritis of pigs
- Bovine genital mycoplasmosis
- Neurotoxin-producing group of Clostridium spp.
- Contagious equine metritis
- Tyzzer's disease
- MYCOTIC AND ALGAL DISEASES: Mycoses
- MYCOTIC AND ALGAL DISEASES: Pneumocystosis
- MYCOTIC AND ALGAL DISEASES: Protothecosis and other algal diseases
- DISEASE COMPLEXES / UNKNOWN AETIOLOGY: Epivag
- DISEASE COMPLEXES / UNKNOWN AETIOLOGY: Ulcerative balanoposthitis and vulvovaginitis of sheep
- DISEASE COMPLEXES / UNKNOWN AETIOLOGY: Ill thrift
- Eperythrozoonosis
- Bovine haemobartonellosis
Pneumonic mannheimiosis and pasteurellosis of cattle
This content is distributed under the following licence: Attribution-NonCommercial CC BY-NC
View Creative Commons Licence details here

Pneumonic mannheimiosis and pasteurellosis of cattle
Previous author: D C Hodgins and P E Shewen
Current authors:
Anthony W. Confer, DVM, PhD, Diplomate ACVP,Regents Professor & Sitlington Endowed Chair, Oklahoma State University, Stillwater, Oklahoma, USA
J D, TAYLOR, Professor, DVM, MPH, PhD, DACVIM (LA), DACVPM, Veterinary Pathobiology, College of Veterinary Medicine, Oklahoma State University, United States
Introduction
Pneumonic pasteurellosis by definition refers to infection of the lung(s) with organisms of the genus Pasteurella.31 The term pneumonic pasteurellosis has served conveniently since the 1960s29, 220 as a means of speaking collectively of pneumonias caused by Pasteurella haemolytica and Pasteurella multocida without committing oneself as to the relative importance of the two agents. With the reclassification of P. haemolytica biotype A strains as Mannheimia haemolytica,11 pneumonic pasteurellosis is an inappropriate name for pneumonia caused by both agents; however, its use is still widespread. The terms pneumonic mannheimiosis and pneumonic pasteurellosis should be used to separate the diseases caused by the two bacteria, M. haemolytica and P. multocida, respectively.
Although these organisms can cause disease in young calves (as a component of enzootic pneumonia of beef, dairy, and veal calves,5, 92, 148, 276 pneumonic mannheimiosis and pasteurellosis are a far greater problem in recently weaned beef calves shortly after entry to feedlots or after long shipments of various kinds as a component of ‘shipping fever’ or undifferentiated bovine respiratory disease (BRD).138, 184, 190, 192, 290 Economic losses to the North American feedlot industry due to respiratory disease have been estimated to be as high as one billion dollars annually,283 and losses to the beef industry in the UK have been estimated at 70 million pounds annually.135, 206 Morbidity rates of 15 to 45 per cent and mortality rates of 1 to 5 per cent are common in newly received feedlot calves;144 it is estimated that 75 per cent of the morbidity125 and 50 to 60 per cent of the mortality78 are attributable to respiratory disease. The major bacterial pathogen involved in beef cattle respiratory disease is M. haemolytica, whereas P. multocida is less frequently involved, but is often the major pathogen in young dairy calf pneumonia.189, 278 In spite of continuing intensive research to develop efficacious vaccines and improved management programmes to prevent pneumonic pasteurellosis in feedlot cattle, success to date has been limited and control of bovine bacterial pneumonia still relies heavily on antibiotics as preventative measures and for treatment.21
Aetiology
Mannheimia haemolytica and P. multocida are Gram-negative, non-motile, non-spore-forming, fermentative, oxidase- positive, facultative anaerobic short rods or coccobacilli of the family Pasteurellaceae.117, 217 Bipolar staining can be demonstrated using Wright's stain. Both grow best in media supplemented with serum or blood; M. haemolytica grows on MacConkey agar, but P. multocida does not. After 24 hours’ incubation on bovine or ovine blood agar plates, colonies of M. haemolytica are round and greyish, with a variable area of ß haemolysis, which can be small, requiring scraping of the colony from the agar to visualize. Colonies of P. multocida are generally round, greyish and non-haemolytic with more heavily encapsulated strains appearing mucoid.117, 217, 224
Mannheimia haemolytica was originally named Pasteurella haemolytica, and two biotypes, A and T, along with 17 serotypes and numerous untypable strains were identified.88, 251 In 1990, biotype A strains were found related by DNA homology, and biotype T strains were related; however, biotype A and T strains had little genetic relationship.27 Biotype T strains became Pasteurella trehalosi and later Bibersteinia trehalosi.28, 252 Through DNA–DNA hybridization and 16S rRNA sequencing, all but one of the A biotypes were designated M. haemolytica. (Angen et al., 1999) Therefore, M. haemolytica consists of the previous P. haemolytica biotype A Serotypes 1,2,5-9, 12-14, 16 and 17.142 Because all M. haemolytica serotypes are derived from biotype A, the designation of M. haemolytica serotypes as A1, A2, etc., often continues, even though it is redundant to include the biotype designation. Serotypes 1 and 6 are the most commonly isolated from BRD.224
Pasteurella multocida has been classified into 5 serogroups (A, B, D, E and F) based on capsular polysaccharide antigen and 16 serotypes (1-16) based on lipopolysaccharide.39, 227 Most P. multocida isolated from bovine respiratory disease are A serogroup, with A:3 being the most common.66
The importance of M. haemolytica and P. multocida in pneumonia of feedlot cattle was suspected in early studies because of their frequent isolation from clinical cases and necropsy specimens. Doubts arose, however, as to whether these agents were primary pathogens, due to difficulties in reproducing clinical disease and pulmonary lesions experimentally and because bacterins did not mediate protection. Identification of numerous pathogenic bovine respiratory viruses that cause lesions or impair clearance of bacteria from the lower respiratory tract encouraged the view that infection with viruses or perhaps Mycoplasma spp., especially Mycoplasma bovis,102 was a necessary prelude to pneumonia with M. haemolytica or P. multocida. Bovine herpesvirus 1 (BoHV) that is also called infectious bovine rhinotracheitis virus,130 parainfluenza-3 (BPIV-3) virus,165 bovine respiratory syncytial virus,268 bovine virus diarrhoea virus,164, 209, 210 and more recently bovine coronavirus160, 260, 103, 159 have been implicated as predisposing to bacterial pneumonia. Challenge models employing primary infection with BoHV or BPIV-3 virus followed by M. haemolytica or P. multocida have been used in studies of pathogenesis and vaccine efficacy.43, 83, 126, 127 It was demonstrated, however, that fibrinous pneumonia could be induced in calves using logarithmic growth phase M. haemolytica or P. multocida alone,6, 89, 90, 98, 202 when sufficient numbers of bacteria (~5 x 109 colony-forming units) are delivered to the lungs by intratracheal or transthoracic routes in non-immune calves.244 In addition, an exotoxin (leukotoxin) specific for ruminant leukocytes was demonstrated in M. haemolytica, 47, 96, 140, 238, 239, 240 establishing that bacterium as a primary pathogen in shipping fever pneumonia. Research has focused on M. haemolytica serotype 1 (S1) as the serotype most commonly isolated from cattle with pneumonia, although S6 is involved approximately 20 per cent of the time.86, 143, 192, 198, 215, 281 In addition, S1 is the dominant serotype in the nasal passages of feedlot calves with acute respiratory disease.86
Although P. multocida has been shown to induce pneumonia when delivered to the lungs in large numbers,6 pulmonary lesions associated with this organism are usually not those of fulminating fibrinous pneumonia.139, 220 Fibrin and necrotic foci can be present; however, lesions are more typically suppurative bronchopneumonia, and as with both bacteria, severity of lesions may be somewhat strain dependent.6, 66, 67, 201 Pasteurella multocida has, therefore, been relegated to a secondary role in pneumonia of feedlot calves,56, 269, 289 although it may be relatively more important as a primary pathogen in disease of young dairy calves.78, 189, 278
Epidemiology
Epidemiological studies of pneumonic pasteurellosis in feedlot calves have been hampered by the difficulty of distinguishing, at the clinical diagnosis level, respiratory disease caused by M. haemolytica or P. multocida from that caused by other bacterial and viral agents.265 This has led to the use of the term ‘undifferentiated bovine respiratory disease’,119, 178, 279, 291 more simply “bovine respiratory disease complex”,12, 106, 175 or even “undifferentiated fever”.236, 273 Case definitions of clinical respiratory disease have been general285 and subjective.221 Clinical diagnosis of BRD also lacks sensitivity in identifying affected animals. A meta-analysis found an estimated pooled sensitivity of clinical diagnosis of 0.27, with a 95 per cent credible interval of 0.14 to 0.92.271 Because of this difficulty in differentiating causative agents or even disease processes, studies may rely upon total morbidity as an outcome measure in field studies.167 Even this approach may underestimate the incidence of BRD, as many untreated cattle demonstrate lung lesions at slaughter.288 Mortality (either overall or respiratory specific, based upon necropsy findings) is more objective than morbidity, but does not identify all affected cattle. Mortality is likely not sensitive enough to facilitate study of most variables of interest. In addition to assessing morbidity and mortality, studies examining efficacy of products or interventions in controlling BRD may also examine production variables, such as average daily gain, feed efficiency, and cost-benefit analysis. Historically,30 the stresses of weaning, adverse weather conditions, change in feed,173, 174 transportation, and mixing of cattle from diverse sources173, 174 have been considered to contribute to the high incidence of respiratory disease observed in recently weaned and assembled feedlot calves. The close association of these events in time has complicated efforts to identify causal relationships. Numerous studies have been conducted to attempt to elucidate the relationship of these practices with BRD, often yielding conflicting or inconclusive results. Weaning prior to shipment appears to be more important than vaccination in preventing BRD.258 Shipment is clearly associated with disease occurrence, but no clear association has been found regarding distance of transport, method, or location within transport trailer.265 Seasonal variation is commonly noted, but this may be confounded by a variety of factors, including typical management practices that result in large numbers of freshly weaned calves being marketed in the autumn. No clear or compelling association can be identified with weather, either. Commingling of calves from multiple sources appears to increase BRD risk, as seen in several studies.223, 232, 258
Higher BRD morbidity and mortality are commonly associated with lighter weight at purchase/arrival, which is assumed to correlate with younger age.17 Bovine respiratory disease (regardless of aetiology) onset within a population of calves coincides with a typical incubation period of common infectious agents (7 to 10 days after initial stressors), with a peak around two weeks after arrival.222 If calves become ill or die more abruptly than that, it is likely they were incubating disease prior to arrival. Historically, morbidity and mortality begin abating soon thereafter, with median time of mortality being approximately three weeks after arrival.222 For unknown reasons, however, there appears to have been a shift in epidemic curves since the 2000s, with certain classes of cattle having a relatively large percentage of BRD cases occurring later in the feeding period.18 Heifers are at a modestly increased risk for BRD as compared to steers.163 Bulls that are castrated after arrival at the feedlot are also at greater risk of BRD than steers castrated and healed prior to purchase.225
It has been questioned whether pneumonic mannheimiosis and pasteurellosis in feedlot calves should be considered highly contagious diseases.269 Although morbidity rates as high as 69 per cent have been reported in the first weeks after feedlot arrival,144 it has been observed that fibrinous pneumonia does not sweep through the feedlot like an epidemic but centres on certain pens.269 This would suggest that characteristics of the calves in the various pens rather than mere exposure to M. haemolytica are critical in determining disease outcomes. In an experimental study, 50 per cent of non-challenged control calves (naive to M. haemolytica) in contact with animals challenged with M. haemolytica developed clinical signs of pneumonic mannheimiosis and responded serologically,98 but it is unclear how well this reflects transmission under field conditions. The question of transmissibility was reviewed by, TAYLOR et al 2010266 where evidence both for and against transmissibility was found. More recent molecular characterization techniques have shown limited dissemination of clonal strains of M. haemolytica throughout the nasopharyngeal microflora within a large population.151 Molecular approaches have also found certain strains are more commonly associated with BRD (perhaps indicating increased virulence compared to other strains).150 Despite the value of this finding, it is unlikely that hyper-virulent vs. less virulent bacterial strains is a notable variable in defining the epidemiology of BRD.
Most recently, molecular studies have focused on the bovine respiratory microbiome with respect to what are the normal nasal, nasopharyngeal, and tracheal microbial flora and what influence various procedures, stresses, age, and feeding period have on that flora. Several studies found differences in the microbiome of calves that remained healthy compared to calves treated for clinical BRD.177, 272 Numerous challenges remain in interpreting or utilizing such results. For example, what considerations are most important - the degree of alteration in the microbiome, the rapidity of changes, or presence (or absence) of certain critical species? Study of the nasal and nasopharyngeal microbiome in beef calves from the time of first processing on the ranch to 40 days after feedlot arrival or throughout the feeding period demonstrated that changes occurred in the microbiome during progression of the study.176 They concluded that although there were changes in the flora, individual animal variation prevented any conclusions concerning disease potential. Additional questions include how stressors impact the microbiome. Another recent study found no significant influence of transportation or commingling of cattle on composition of the nasopharyngeal or tracheal microbial flora.264 In contrast, a single injection of oxytetracycline or tulathromycin upon entry to the feedlot resulted in measurable changes in nasopharyngeal microbiota.123 Those same authors found distinct differences in nasopharyngeal and tracheal microcolonies in healthy cattle and pen-mates with pneumonia with a higher abundance of M. haemolytica and P. multocida in pneumonic compared to healthy cattle.272 This field of study shows great promise for further understanding pathogenesis and epidemiology; however, it is still in its infancy.
Pathogenesis
The vast majority of studies of the pathogenesis of pneumonic mannheimiosis/pasteurellosis have been in the context of M. haemolytica. It has not been clearly demonstrated whether similar processes are responsible for disease associated with P. multocida.
Stress-related factors such as weaning, adverse weather conditions, change in feed, transportation over long distances, and mixing of cattle from various sources have long been associated with pneumonic mannheimiosis and pasteurellosis in feedlot calves.30, 76, 267 Numerous studies have attempted to clarify the induced pathogenic mechanisms. Cold stress (chilling of calves with cold water) increases plasma cortisol levels transiently, but does not affect histamine or bradykinin levels.248 Enhanced proliferation of M. haemolytica in the nasopharynx of calves following an abrupt change in climate from cold and dry to warm and humid has been noted, and that may be related to the effects of stress-related chemicals such as epinephrine on M. haemolytica biofilm dispersal.136, 208 Transporting recently weaned calves leads to the elevation of plasma cortisol levels for three days or more and depressed lymphocyte blastogenic responses.77 Transporting heifers during high ambient temperatures increased plasma cortisol and modified behaviour.267 Decreases in serum complement activity as calves move from the auction market to the feedlot have been documented.216 Transportation and weaning stress decreased the number of T lymphocytes, shifted dominant immune responses from TH1 to TH2, and caused neutrophilia due to release of immature neutrophils from the bone marrow, decreased neutrophil margination along endothelial lining of vessel walls, and a decrease in neutrophil apoptosis.72 The effects of mixing of calves (during transportation to the feedlot or after sorting at the feedlot) on the prevalence of respiratory disease may result from the stresses of interacting with strange calves, or may reflect increased opportunities to contact infectious agents.128 The relative importance of these influences continues to be debated.223
Both M. haemolytica and P. multocida constitute part of the normal flora of the nasopharynx of healthy calves, where they exist in polysaccharide biofilms,32, 33 but may be undetectable or detected in low numbers by routine culture.20, 79 Although these pathogens are present in the nasopharynx, recent studies indicate their absence from the paranasal sinuses.193 Changes in the flora of the nasopharynx of calves from before weaning until after arrival at the feedlot have been investigated, especially in recent years using metagenomics.122, 292 In one study, isolation of M. haemolytica was infrequent from nasal swabs collected at the farm of origin, but increased at auction markets, and was quite marked after arrival at the feedlot.86 Serotyping of the isolates indicated that M. haemolytica S2 was most common on the farm, but serotype S1 predominated in nasal swabs from calves in the feedlot and from lung cultures from fatal cases of respiratory disease. Currently, studies of M. haemolytica using genotyping of isolates are being conducted, which may provide a better understanding of colonizing, pathogenic M. haemolytica. A recent study demonstrated prevalence of various M. haemolytica serotypes in European cases of BRD to be similar to that in North American BRD in that S1 was present in 59 per cent, S6 present in 22 per cent and S2 in 18 per cent of cases.9 Overall, culture of nasopharynx samples from calves upon arrival in a feedlot is of limited value.
Several studies have investigated serotypes of M. haemolytica isolated from cattle in sub-Saharan African countries. The examination of 48 isolates from primarily healthy cattle in Kenya revealed a predominance of serotypes S1and S2.194 A progressive shift in nasal flora from more frequent isolation of serotype S1 to more frequent isolation of S2 was noted in a group of heifers during transportation. Of 96 isolates from diagnostic specimens from cattle in South Africa, 30 per cent were untypable, and serotype S1 was isolated from 40 per cent of cases.198 Serotypes 2, 6, 23, 24 were also represented.
Tonsillar tissue, specifically, has been identified as a reservoir for M. haemolytica.81, 85 Calves may be negative for M. haemolytica on culture of nasal swabs, but positive on culture of the tonsils.84 Not only does the frequency of isolation of M. haemolytica S1increase as calves move to the feedlot, but the number of bacteria also increases rapidly.79 When high numbers of M. haemolytica are present on the nasal mucosa of calves, the bacteria are inhaled into the lungs (although they are not present in exhaled air).103 In healthy calves, lung clearance of inhaled M. haemolytica is highly efficient, with the elimination of 90 per cent of an administered dose within four hours.159
Infection with BPIV-3 virus or BoHV-1 can lead to the proliferation of M. haemolytica in the nasopharynx of calves that had previously reduced their numbers of M. haemolytica to undetectable levels.79 Virus infection can mediate colonization of the nasal passages by M. haemolytica or P. multocida even in the presence of detectable titres of antibodies in serum and nasal secretions.83, 93 Exposure of bronchial epithelial cells to BoHV-1, M. haemolytica , or both causes marked inductions of genes responsible for inflammatory processes.195 Increased elastase activity in the mucus of the nasal passages was documented in calves following experimental infection with BoHV-1, and preceding colonization by M. haemolytica.36,23 Elastase may act by cleaving fibronectin on the surface of epithelial cells, permitting colonization by Gram-negative bacteria.20, 36 Pasteurella multocida outer membrane protein OmpA has been shown to enhance colonization by binding to fibronectin.65 Infection with BPIV-3 virus leads to impaired clearance of bacteria from the lungs.165 Bovine herpesvirus 1, BPIV-3 virus and bovine virus diarrhoea virus have been shown to impede ciliary activity of tracheal epithelial cells in vitro.230 The roles of viral-bacterial synergism289 and other mechanisms in the pathogenesis of pneumonic pasteurellosis have been reviewed.20, 283
There is experimental evidence that neutrophils play a considerable role in the induction of lung lesions following infection with M. haemolytica. Calves depleted of neutrophils before challenge with live M. haemolytica have minimal or reduced lung lesions.35, 249 The contents of primary and secondary granules, as well as cytosolic enzymes, are released from bovine neutrophils following exposure to live M. haemolytica or its leukotoxin, mediating acute lung injury.280 Pulmonary intravascular macrophages and alveolar macrophages are also important mediators of inflammation in early lung lesions.282
Multiple products and components of M. haemolytica S1 have been proposed as virulence factors, including adhesins,124, 149 capsular polysaccharide,38, 58, 60 fimbriae,186, 187 iron-regulated outer-membrane proteins,94, 185, 256 leukotoxin,96, 240, 241 lipopolysaccharide,57 lipoproteins,61, 196 neuraminidase,87, 262, 263 a serotype-specific antigen,100, 162 sialoglycoprotease,1, 156 IgA protease, and transferrin binding proteins.13, 50, 199, 211, 247 The adhesin protein, capsular polysaccharide, fimbriae, sialoglycoprotease and neuraminidase may have roles in the attachment of M. haemolytica and its colonization of cells of the respiratory tract of calves.20, 186, 188, 283 The capsular polysaccharide also has anti-phagocytic properties,41 and increases directed migration of neutrophils.62 The sialoglycoprotease, by cleaving bovine IgG1 or host cell surface proteins, may reduce the effectiveness of opsonizing antibodies and enhance colonization.155 Transferrin-binding proteins and other iron-regulated proteins enable M. haemolytica to proliferate in vivo in spite of the low iron environment normally maintained by the host. Lipopolysaccharide as an inducer of inflammation has a central role in the development of vascular lesions in lung tissue and activation of proinflammatory mediators.245, 246, 283 Leukotoxin has multiple effects on bovine leukocytes, mediating cell death by both cytolytic46 and apoptotic mechanisms.157, 259 Lower concentrations of leukotoxin inhibit lymphocyte (blastogenic) responses171 and reduce the chemiluminescent and bactericidal responses of phagocytic cells.42, 55 Lytic effects on platelets probably contribute to the exudation of fibrin and formation of thrombotic lesions in infected lung tissue.48
In summary, colonization (or recolonization) of the upper respiratory tract of calves by M. haemolytica S1 may occur rapidly during the process of weaning, marketing, transportation and admission to a feedlot. Environmental factors and/or viral infection may facilitate the dramatic increase in population of M. haemolytica in the nasopharynx. Inhalation of M. haemolytica in increased numbers, in association with stress or virus-associated impairment of bacterial clearance, permits rapid proliferation of the organism in the lungs. The influx of neutrophils in response to the presence of lipopolysaccharide and capsular polysaccharide is followed by lysis of these cells due to the effects of leukotoxin, with the release of the contents of primary and secondary granules. This event, in combination with inflammatory effects due to lysis of platelets by leukotoxin and the effects of lipopolysaccharide and leukotoxin on alveolar and intravascular macrophages, leads to vascular damage, exudation of fibrin, the development of oedema in the alveoli and interlobular septa, and the accumulation of fluid and fibrin in the thoracic cavity. The compromising of the vascular supply soon leads to necrosis of affected areas of lung parenchyma.
Pasteurella multocida virulence factors and respiratory pathogenesis are less understood than those associated with M. haemolytica.66, 112 Suppurative bronchopneumonia occurs when bronchial colonization with P. multocida initiates suppurative bronchitis with progressive spread along airways resulting in an obviously bronchiole-centered lesion within each lung lobule. Isolates associated with BRD are usually serogroup A, whereas serogroups B and E are associated with ruminant haemorrhagic septicaemia. Serogroup D strains, as well as some serogroup A strains, can produce a cytolytic toxin, Pasteurella multocida toxin (dermonecrotic toxin) that is associated with atrophic rhinitis of pigs.40 In the past, toxigenic serogroup D isolates were rarely associated with bovine respiratory disease. However, in a recent study from Spain, toxigenic serogroup A and D strains were isolated from pneumonia in sheep.44 Strains of P. multocida serogroup A that are heavily encapsulated have been shown to resist phagocytosis and killing by bovine neutrophils.170 Lipopolysaccharide of P. multocida has carbohydrate moieties that are similar to the carbohydrate component of host glycoproteins, making it likely that LPS mimicry of host molecules could play a role in the survival of P. multocida in the host.111 In vivo studies in mice demonstrated that P. multocida LPS and outer membrane proteins interact with TLR4 and CD14, stimulating release of numerous proinflammatory cytokines.213 In a dose- and time-dependent manner, P. multocida LPS can also stimulate leukocyte proliferation and leukocyte death via mitochondrial dysfunction and caspase activation.204 Expression of various genes for adhesins, outer membrane proteins OmpA and OmpH, iron-regulated membrane proteins, and haemoglobin-binding proteins have been shown to be different between virulent and less virulent P. multocida strains and among strains from different hosts.74, 212, 213, 242, 243
Clinical signs
Clinical signs in calves following experimental challenge with M. haemolytica or P. multocida closely resemble those occurring in feedlot calves with pneumonic mannheimiosis/pasteurellosis;6, 90, 98, 244, 286 effects due to M. haemolytica are generally more severe than those due to P. multocida.5 Observed signs in calves challenged by the intratracheal route include depression (drooping ears, reluctance to move),98 inappetance,284, 286 increased respiratory rate and effort, moist rales on lung auscultation with occasional moist coughing,90 and recumbency.284 A serous to mucoid or purulent nasal discharge may be present.286 Rectal temperatures over 40°C are common6 and may be as high as 41,5 °C.286 The naturally occurring disease in feedlot calves may be acute and fulminating, with calves dying before they are detected as ill by feedlot personnel269 or taking a more chronic course.79, 289 Increased lachrymation is common, and mucopurulent nasal discharges may result in encrusted muzzles.289 Dyspnoea in severe cases may lead to oral breathing289 with an expiratory grunt.219 Calves may adopt a distressed stance, with elbows abducted and neck extended.289 Moist rales may progress to dry rales and pleuritic friction rubs.219 During a disease outbreak up to 20 per cent or more of calves that appear clinically normal may have fever of 40 °C or more; some of these will progress to be patently ill, while the rest will recover without treatment.219
Pathology
It is common to culture or detect with multiplex PCR multiple infectious agents in pneumonic bovine lungs.91, 152, 166, 287, 294 The lesions associated with pneumonic mannheimiosis have been reviewed40, 201, 220, 289 and are basically those of fibrinous pleuropneumonia (Figure 1). Commonly, the cranioventral one- to two-thirds of the lung are bilaterally consolidated and of firm and heavy consistency (hepatization). Lobules in the affected areas are red, grey, or nearly black, and in a spectrum of stages of the pneumonic process, imparting an appearance to those areas that have been described as ‘marbled’ (Figure 2).220 A clear separation exists between pneumonic and non-pneumonic areas of the lung. Acute fibrinous or serofibrinous pleuritis often accompanies the pneumonic lesions, with sheets of fibrin loosely or firmly adherent to the parietal and visceral pleura and/or pericardium. Large volumes of straw-coloured thoracic fluid are occasionally encountered.220 Oedema and deposits of fibrin distend the interlobular septa in affected areas and interlobular lymphatic thrombi may be visible. In more chronic lesions, numerous areas of coagulative necrosis are present,220, 289 delimited by pale fibrous tissue. This fibrous capsule becomes progressively thicker with time in calves surviving the acute disease process.3 Fibrin deposits in the pleural cavities may become organized to form extensive fibrous adhesions.
Gross lesions of pneumonic pasteurellosis are most commonly seen in BRD of young dairy calves and most often associated with P. multocida infection though other respiratory bacteria may also produce the lesion.10, 40, 66, 201 Suppurative bronchopneumonia occurs when bronchial colonization of bacteria initiates suppurative bronchitis with progressive spread along airways resulting in bronchiole-centered lesion within each lung lobule. The pneumonia is bilateral, cranioventrally distributed, and moderately firm. In acute lesions, affected lobes are fairly uniform in colour varying from pink, pink-grey, dark red, red-grey, or grey with minimal to mild interlobular septal oedema. On cut surface within lobules, there are variably-sized, partially discrete tan to grey foci indicative of a pattern of bronchiolar and peribronchiolar inflammation from which purulent to mucopurulent exudate can often be expressed. Pleuritis is usually not present; however, if present, it consists of small foci of pleural dullness to small clusters of fibrin strands. Remaining areas of lobules are pink to dark red representing various amounts of inflammation, congestion, and atelectasis.
Histological lesions of pneumonic mannheimiosis vary with the stage of progression of the disease. In experimental cases, neutrophils, macrophages, oedema and fibrin are prominent in the alveoli by six hours post-inoculation.45 Subsequently, oedema, fibrin and congestion or haemorrhage become more prominent in the alveoli. At a later stage, ‘swirly’ or ‘streaming’ or ‘oat-shaped’ dark-staining macrophages with pyknotic, hyperchromatic nuclei are typically found in the alveoli (Figure 3).220, 289 Large areas of coagulative necrosis, often involving nearly entire lobules, surrounded by degenerating and intact leukocytes and fibrin are often present. Thrombosis of septal lymphatic vessels is present in severe cases.220 Arterial thrombosis is often present in more subacute to chronic lesions.40
Histologic lesions of pneumonic pasteurellosis are classical, suppurative bronchopneumonia characterized by bronchioles and adjacent alveoli distended with degenerating and viable neutrophils, fibrin, and protein-rich oedema.40, 68 Segmental necrosis of bronchiolar epithelium may be present along with intra-alveolar haemorrhage. Over time, macrophages and lymphocytes increase within bronchioles and alveoli. Foci of necrosis may occur within affected alveoli, which may progress into foci of abscessation.
Diagnosis and differential diagnosis
Ante mortem diagnosis of BRD is typically based upon signalment, history, and clinical signs. For recently weaned, newly received feedlot calves, antibiotic treatment is usually initiated based on clinical signs without awaiting an aetiological diagnosis, because of the high incidence of pneumonic mannheimiosis and pasteurellosis in this class of calves and the expected rapid progression of disease signs.105, 219 Suspicion increases with increasing epidemiological risk factors, as outlined above. History is often incomplete, as calves are typically purchased at auction markets and commingled, with no knowledge of prior management practices. Various clinical scoring systems have been devised, with the most common using a combination of criteria involving evaluation of depression/mental obtundation; appetite (manifested as rumen fill, as well as approach to bunk when feed is delivered); respiratory signs (including nasal discharge, coughing, respiratory effort, and dyspnoea), and body temperature (with varying definitions of fever, depending upon type of cattle, time of day, geographic location, and season).258 While these criteria are in no way specific to bacterial pneumonia, antibiotics are commonly administered even when a viral agent is suspected, in order to control secondary bacterial infections.105
More detailed examination of the respiratory tract has historically not been practised, since, in general, BRD is easy to distinguish from more discrete feedlot health issues (such as lameness, bloat, “bullers,” etc.). The exception to this is ruminal acidosis, which may mimic many of the non-respiratory signs, and even some respiratory signs (as the respiratory tract assists in acid-base regulation). This overlap of clinical signs can complicate BRD diagnosis, both in production and research settings.226 Clinical BRD diagnosis can be enhanced by detecting elevated serum acute-phase proteins, particularly haptoglobin, and thoracic ultrasound evaluation.182 Culture of nasal swabs is of doubtful diagnostic value due to the high numbers of M. haemolytica present in the nasopharynx of newly arrived feedlot calves regardless of their health status,79 and the lack of correlation between nasal and lung isolates in individual calves.4 Bronchoalveolar lavage along with bacterial culture or multiplex PCR can give a better assessment of bacteria involved in pneumonia.287 Evaluation of results from antimicrobial susceptibility testing of isolates from affected lung, especially from untreated cases, may provide useful information for therapeutic decisions for the rest of the group.80 However, the correlation of susceptibility to clinical outcome is unclear.153
Other respiratory conditions that may be mistaken for pneumonic mannheimiosis/pasteurellosis include pneumonia due to Histophilus somni or Mycoplasma spp. infection as well as bovine respiratory syncytial virus, BoHV-1 (or other viruses infecting the respiratory tract), interstitial pneumonias, and sporadic conditions, such as lung abscesses and aspiration pneumonia.105, 219 The finding of fibrinous or fibrinopurulent bronchopneumonia on necropsy is highly suggestive of pneumonic mannheimiosis, although H. somni, also a member of the family Pasteurellaceae, can cause fibrinous lesions.79, 105 For a definitive diagnosis, culture or multiplex PCR of affected lung tissue is required.7, 287, 294
Control
Pneumonic mannheimiosis or pasteurellosis appears to largely be a management disease resulting from incompatibility between the biology of calves (and their microbiota) and the managing and/or marketing systems of humans. Calves that move directly from a ranch into feedlots without moving through sales yards, and without mixing with calves from other sources, can be expected to suffer notably lower morbidity than calves undergoing commingling, extended and/or repeated transport, or other stressors. While vaccines and antibiotics can be useful in controlling pneumonic mannheimiosis or pasteurellosis, basic changes in when and how calves are weaned, sold, and transported to feedlots would have a profound impact on the prevalence of disease. Despite this recognition, much uncertainty remains in understanding all contributing causes of BRD, and thus how to truly control its occurrence. One of the most consistent features of BRD is the enormous variability that can occur across operations following similar procedures, or even from year to year on the same operation.141, 253 Thus, while producers should be encouraged to castrate at a young age, vaccinate, wean on the farm/ranch of origin, and perform other tasks commonly referred to as preconditioning, they should be warned that unexpected morbidity may still occur.
Antibiotics
Use of oral antimicrobials (either in feed or in water) to treat, control, or prevent BRD has been extensively examined. Products available for these purposes in the United States (US) include oxytretracycline alone, sulfadimethoxine (and other sulfa compounds) alone, oxytetracycline and sulfamethazine in combination, oxytetracycline and neomycin in combination, and tilmicosin. Evidence for efficacy of most of these products is minimal, and the regulatory environment in the EU and the US makes oral antimicrobials more difficult to justify and utilize.
Injectable antibiotics are employed extensively in the feedlot industry in North America in attempts to prevent and treat pneumonic mannheimiosis, pasteurellosis, and other infectious diseases not distinguished from pneumonic pasteurellosis by feedlot personnel. Antibiotics are rarely selected on the basis of in vitro sensitivity of isolates from nasal or pharyngeal swabs. Isolates from these sources may not accurately reflect organisms present in the lower respiratory tract of the same animal.4 Necropsy specimens from calves treated with antibiotics also do not necessarily provide relevant information as to the antibiotic sensitivities of the organisms initiating the pneumonia, and may not be related to treatment history.153
In most published studies examining the efficacy of antibiotics against disease in feedlots no attempt to distinguish pneumonic mannheimiosis or pasteurellosis from respiratory conditions caused by other bacteria or by viruses is made.158, 178, 279 The term ‘undifferentiated fever’ has been considered synonymous with ‘BRD complex’ by some workers.131 Thus a succession of antimicrobial drugs have been examined for efficacy against undifferentiated respiratory disease under field conditions, including penicillin,24, 178 oxytetracycline,24, 108, 178 trimethoprim/sulfadoxine,24, 108, 178 ampicillin,26, 158 tilmicosin,101, 119, 235 florfenicol,119, 131, 158 ceftiofur,114, 115 enrofloxacin,200, 233,75, 231 tulathromycin,145, 146,8 gamithromycin,161, 229 and others. Although many of these antimicrobials historically had some degree of efficacy for treatment of bovine respiratory disease, with the wide array of products now available there is little indication for use of penicillin, ampicillin, and sulphonamides. Resistance to oxytetracycline is quite prevalent among M. haemolytica and P. multocida, limiting its efficacy, as well.272 The efficacy of labelled antimicrobials for treatment of BRD is extensive and compelling.70 More controversial is the metaphylactic use of antimicrobials. Metaphylaxis is defined as the administration of parenteral antimicrobials to a population of animals based upon a threshold of morbidity or presence of characteristics that suggest high risk for BRD. Many of the products labelled to treat BRD are also labelled for metaphylactic usage. While the utility of metaphylaxis varies notably with the class of cattle and morbidity that occurs in the untreated controls, it is clear that metaphylaxis reduces overall morbidity and mortality.21, 70 Concern exists regarding, and research continues in examining, the role of metaphylaxis in stimulating antimicrobial resistance, both in BRD pathogens and in other microorganisms.
Emergence of antimicrobial resistance among M. haemolytica and P. multocida since the early 2000s has complicated treatment recommendations. Antimicrobial resistance is generally much higher in bacterial isolates obtained from calves previously treated for BRD than from those collected from untreated calves.69, 168 Nonetheless, it is unclear how much resistance contributes to treatment failure; for example, there is often less-than-perfect concordance between antimicrobials used to treat calves and the resistance profiles seen in pathogens recovered from those calves.153 Thus, the question remains unanswered whether resistance is what allowed the organisms to persist and ultimately cause death, or if the cattle were at great risk of death due to other causes, and resistance simply emerged in them as a result of selection pressure. There is evidence that resistance can disseminate throughout a group of cattle via integrative conjugative elements (ICE).197 These findings suggest that antibiograms of isolates from untreated cattle, if available, may be useful in guiding treatment decisions for other members of the group.
Vaccines
Vaccines intended for prevention of respiratory disease in feedlot cattle have been manufactured for nearly 100 years.190 Numerous commercial M. haemolytica and P. multocida vaccines are available worldwide. Evaluation of vaccine efficacy in calves against M. haemolytica and P. multocida requires controlled studies involving challenge with virulent bacteria; however, there are difficulties associated with those studies in part because of problems in defining objective outcome measures,221 and because of difficulties in achieving adequate group sizes to obtain acceptable statistical power.285 Comparison of experimental vaccination data from various published studies is complicated by variations in challenge methods used.51 Vaccine efficacy is also difficult to establish in field studies in part because morbidity and mortality rates, infectious agents and stressors, and genetic makeup of cattle vary widely among studies.222, 275 A single field trial is considered inadequate to assess the economic impact of a particular vaccine on respiratory disease in feedlots.285 Mannheimia haemolytica and P. multocida vaccines have been reviewed, and efficacy of commercial vaccines has been assessed retrospectively.51, 66, 154, 205
Early bacterins were prepared from cultures of Bacillus bovisepticus (which has since been divided into the species M. haemolytica and P. multocida; following field trials their efficacy was questioned181 or they were found to have detrimental effects.76 More recently, bacterins prepared from M. haemolytica have been reported to have no clear beneficial effect,107, 172 or to have detrimental effects and for the most part are no longer commercially available.90, 234, 284Pasteurella multocida bacterins, however, are still in use, but there is little evidence of efficacy.51
Live M. haemolytica vaccines have been investigated19, 190 and marketed,118 but protection studies have yielded variable results, and one report found septicaemia of the previously marketed M. haemolytica vaccine strain in calves.191, 214, 250, 293 Use of antibiotics in cattle vaccinated with live M. haemolytica (within seven days after or three days before vaccination) is not recommended, due to inhibitory effects on vaccine bacterial replication.118 The widespread use of antibiotics in calves arriving at feedlots makes the use of live bacterial vaccines impractical. Recently, the live streptomycin-dependent M. haemolytica and P. multocida vaccine that has been in use parenterally for many years was approved for both parenteral and intranasal vaccination.255
Identification of the importance of the leukotoxin produced during logarithmic phase growth in the pathogenesis of pneumonia96, 238, 240 led to the development of a commercial, cell-free, M. haemolytica S1culture supernatant vaccine.237, 241 In experimental trials using two doses of vaccine at an interval of 21 days, efficacy against moderate to severe pneumonia ranged from 60 to 70 per cent.237 Results from field trials were variable.22, 134, 270
Numerous other antigens of M. haemolytica have been documented in logarithmic phase culture supernatant, including surface antigens involved in agglutination reactions,241 capsular polysaccharide,60 lipoproteins,61 outer membrane proteins,13 and sialoglycoprotease,1 and may contribute to vaccine efficacy. Numerous immunogenic outer membrane proteins and lipoproteins have been demonstrated and may contribute to immunity against M. haemolytica. These include PlpE, OmpA, Gs60, Serotype 1- specific antigen, and transferrin binding proteins.14, 15, 52, 169, 183
Since the initial M. haemolytica subunit vaccine, various companies have introduced other subunit or subunit-enriched vaccines consisting of outer membrane extracts,257 or extracted antigens enriched with recombinant leukotoxin,19, 274, 275, 277 or a bacterin with added culture supernatant antigens.19, 257 In 1999, a vaccine based on antigens expressed under iron-limiting conditions was licensed.71, 99 Serological responses to selected commercial M. haemolytica vaccines have been compared.52, 54, 257 Field studies with bacterin-toxoid vaccines demonstrated variable results, although positive effects on mortality or morbidity were seen in some studies.82, 167, 277
Recent studies have focused on the induction of local immunity in the nasopharynx to M. haemolytica by mucosal delivery of antigen, thereby reducing colonization. Viral vectors replicating in the upper respiratory tract and expressing antigens of M. haemolytica,19, 25 oral administration of M. haemolytica antigens encapsulated in alginate microspheres,34 recombinant outer membrane proteins and leukotoxin16, 53 and oral administration of modified live M. haemolytica have been studied.37 None of those were commercialized.
The protective antigens of P. multocida have received less attention, but outer membrane proteins,2, 64, 97 fimbriae,2 capsular polysaccharide,2 neuraminidase,261 OmpA63, 95 and transferrin binding proteins2 are candidate antigens for subunit vaccines for use in cattle.
Vaccines targeting viral agents of respiratory disease (BoHV-1, BPIV-3 virus, bovine respiratory syncytial virus, bovine virus diarrhoea virus) have been advocated190 in the prevention of pneumonic mannheimiosis/pasteurellosis in feedlot animals, on the basis that immunity to viral agents could reduce susceptibility to bacterial invaders by preserving the integrity of mucosal barriers and bacterial clearance mechanisms.
In spite of advances in identification of relevant organisms and antigens for inclusion in vaccines, the impact of vaccination on morbidity and mortality in the feedlot remains limited.73, 172, 179, 180, 190 To a large degree, this may reflect the conditions under which cattle are vaccinated. Although many vaccine manufacturers recommend that stressed or recently shipped cattle should not be vaccinated,118, 129 most vaccines against respiratory disease are administered on arrival at feedlots.19, 22 In many cases, vaccination on arrival delivers vaccine antigens after infection has already taken place,19 making it impossible for the animal to mount a timely immune response. Vaccines containing antigens of multiple agents are common and interactions between vaccine products can occur. A modified live BoHV vaccine has been shown to suppress immune responses to a M. haemolytica vaccine administered at the same time.110 While recommendations and practices continue to evolve, the utility and appropriateness of vaccination at arrival has been questioned. Recent studies found benefit to delaying vaccination until calves have become acclimated to the feedlot (the amount of delay may vary from 10 to 30 days).104, 228 A meta-analysis, however, found no difference in vaccination at arrival vs. delayed.254
The kinetics of immune responses to respiratory pathogens in calves from birth to weaning, and from weaning to the onset of feedlot respiratory disease have not been studied systematically. It is unclear what proportion of beef calves have been primed to antigens of M. haemolytica S1 by the time of weaning. In one field study it was found that a significant increase in serum antibody titres to M. haemolytica leukotoxin occurred after primary vaccination on arrival at the feedlot, suggesting that many calves had been primed by natural exposure and had mounted anamnestic responses after a single dose of vaccine.277 Following an experimental study in young Holstein calves, it was also concluded that a single dose of M. haemolytica vaccine was as efficacious as two doses in increasing serum antibody titres and in protecting against experimental challenge;59 this again suggested priming by natural exposure. If most calves leave the ranch of origin primed by natural exposure, then secondary immune responses to the rapidly increasing numbers of M. haemolytica in the nasopharynx must be insufficient in many cases to control the disease process. For vaccination to be effective in these animals it must provide a more potent antigenic stimulus than that occurring naturally, and/or the stimulus must occur earlier. Some calves may reach weaning age immunologically naive to M. haemolytica S1.77, 120 If vaccination is to protect such naive calves, then management changes which allow earlier vaccination will be necessary.
Diversity of immune experience (e.g. calves immune to some respiratory pathogens, primed for anamnestic responses to others, infected and mounting an early primary response to some and naive to the rest) on feedlot arrival could contribute to the variable efficacy of particular vaccines.134, 270 If calves in a particular trial arrive at the feedlot with a high level of immunity to the pathogen targeted by the vaccine in question, then the perceived benefits of vaccination will be low, although morbidity with respiratory disease due to other pathogens could still be high. Serological findings have been published in conjunction with clinical findings in some vaccine studies,110, 277 but not in others.134, 270
To summarise, commercial vaccines are available for most of the agents implicated in BRD, including viral and bacterial pathogens. In general, these vaccines are effective in generating immune responses, and can be an integral part of a BRD control programme. Nonetheless, it is critical to recognize that vaccination alone is not an efficacious BRD control programme.
Preweaning and preconditioning programmes
Programmes to prepare cattle for entry to feedlots by preweaning (weaning 14 to 28 days before shipment off farm) or preconditioning (preweaning, castration, dehorning, and vaccination with selected vaccines 21 to 45 days before shipment137) generally reduce BRD morbidity and mortality, but can still produce variable results. ‘Certified Precondition for Health’ preconditioning programmes for beef calves have been established in numerous states of the US since the 1960s,113, 218 but have made only limited impact on the feedlot industry.132 A review of controlled experiments of preconditioned calves found an average reduction in morbidity of 23 per cent and a decrease in mortality of 0,7 percentage units.49 The economic benefits to both cow/calf producers and feedlot operators of preconditioning have been questioned.49, 73, 132, 133, 137, 207 In general, economic benefits of preconditioning are derived from weight gain of calves during that time, rather than a premium collected at marketing.116
Accumulating evidence suggests that calves can be vaccinated successfully at a relatively young age in spite of persisting titres of maternal antibodies. Serum antibody responses to the leukotoxin and capsular polysaccharide of M. haemolytica S1 have been reported in dairy calves vaccinated at six and eight weeks of age with a commercial culture supernatant vaccine.121 The results obtained in beef calves vaccinated at three and five weeks of age,275 at one and two months of age,274 or at two months of age109 with a commercial vaccine containing genetically attenuated leukotoxin with extracted antigens of M. haemolytica, have also demonstrated significant increases in serum antibody titres post-vaccination. Vaccination of calves against respiratory viruses, in the presence of maternal antibodies, may induce immune priming147, 203 with the potential for anamnestic responses after weaning. A management programme of vaccination at branding combined with revaccination within a day of weaning84 could provide a means to maximize immunity by the time of feedlot entry, with minimal extra labour costs.
In conclusion, given the current marketing procedures used in cattle industries mannheimiosis/pasteurellosis pneumonia can be reduced and managed through use of vaccines, antibiotics and good management practices. However, even the most fastidious utilization of these tools seems unlikely to eliminate the condition.
References
- ABDULLAH, K. M., UDOH, E. A., SHEWEN, P. E. & MELLORS, A., 1992. A neutral glycoprotease of Pasteurella haemolytica S1specifically cleaves O-sialoglycoproteins. Infection and Immunity, 60, 56-62.
- ADLER, B., BULACH, D., CHUNG, J., DOUGHTY, S., HUNT, M., RAJAKUMAR, K., SERRANO, M., VAN ZANDEN, A., ZHANG, Y. & RUFFOLO, C., 1999. Candidate vaccine antigens and genes in Pasteurella multocida. Journal of Biotechnology, 73, 83-90.
- ALLAN, E. M., GIBBS, H. A., WISEMAN, A. & SELMAN, I. E., 1985. Sequential lesions of experimental bovine pneumonic pasteurellosis. Veterinary Record, 117, 438-442.
- ALLEN, J. W., VIEL, L., BATEMAN, K. G., ROSENDAL, S., SHEWEN, P. E. & PHYSICK-SHEARD, P., 1991. The microbial flora of the respiratory tract in feedlot calves: Associations between nasopharyngeal and bronchoalveolar lavage cultures. Canadian Journal of Veterinary Research, 55, 341-346.
- AMES, T. R., 1997. Dairy calf pneumonia: The disease and its impact. Veterinary Clinics of North America, Food Animal Practice, 13, 379-391.
- AMES, T. R., MARKHAM, R. J. F., OPUDA-ASIBO, J., LEININGER, J. R. & MAHESWARAN, S. K., 1985. Pulmonary response to intratracheal challenge with Pasteurella haemolytica and Pasteurella multocida. Canadian Journal of Comparative Medicine, 49, 395-400.
- AMMAR, A. M., ABD EL-AZIZ, N. K., ABD EL WANIS, S. & BAKRY, N. R., 2016. Molecular versus conventional culture for detection of respiratory bacterial pathogens in poultry. Cellular and Molecular Biology (Noisy-le-grand), 62, 52-56.
- AMRINE, D. E., WHITE, B. J., LARSON, R. L. & MOSIER, D. A., 2014. Pulmonary lesions and clinical disease response to Mannheimia haemolytica challenge 10 days following administration of tildipirosin or tulathromycin. Journal of Animal Science, 92, 311-319.
- ANDRES-LASHERAS, S., ZAHEER, R., KLIMA, C., SANDERSON, H., ORTEGA POLO, R., MILANI, M. R. M., VERTENTEN, G. & MCALLISTER, T. A., 2019. Serotyping and antimicrobial resistance of Mannheimia haemolytica strains from European cattle with bovine respiratory disease. Research in Veterinary Science, 124, 10-12.
- ANDREWS, G. A. & KENNEDY, G. A., 1997. Respiratory diagnostic pathology. Veterinary Clinics of North America: Food Animal Practice, 13, 515-547.
- ANGEN, O., MUTTERS, R., CAUGANT, D. A., OLSEN, J. E. & BISGAARD, M., 1999. Taxonomic relationships of the [Pasteurella] haemolytica complex as evaluated by DNA-DNA hybridizations and 16S rRNA sequencing with proposal of Mannheimia haemolytica gen. nov., comb. nov., Mannheimia granulomatis comb. nov., Mannheimia glucosida sp. nov., Mannheimia ruminalis sp. nov. and Mannheimia varigena sp. nov. International Journal of Systematic Bacteriology, 49, Pt 1, 67-86.
- ANHOLT, R. M., KLIMA, C., ALLAN, N., MATHESON-BIRD, H., SCHATZ, C., AJITKUMAR, P., OTTO, S. J., PETERS, D., SCHMID, K., OLSON, M., MCALLISTER, T. & RALSTON, B., 2017. Antimicrobial susceptibility of bacteria that cause bovine respiratory disease complex in Alberta, Canada. Frontiers in Veterinary Science, 4, 207.
- AYALEW, S., CONFER, A. W., HARTSON, S. D., CANAAN, P. J., PAYTON, M. & COUGER, B., 2017. Proteomic and bioinformatic analyses of putative Mannheimia haemolytica secretome by liquid chromatography and tandem mass spectrometry. Veterinary Microbiology, 203, 73-80.
- AYALEW, S., CONFER, A. W., HARTSON, S. D. & SHRESTHA, B., 2010. Immunoproteomic analyses of outer membrane proteins of Mannheimia haemolytica and identification of potential vaccine candidates. Proteomics, 10, 2151-2164.
- AYALEW, S., SHRESTHA, B., MONTELONGO, M., WILSON, A. E. & CONFER, A. W., 2011. Immunogenicity of Mannheimia haemolytica recombinant outer membrane proteins serotype 1-specific antigen, OmpA, OmpP2, and OmpD15. Clinical and Vaccine Immunology, 18, 2067-2074.
- AYALEW, S., STEP, D. L., MONTELONGO, M. & CONFER, A. W., 2009. Intranasal vaccination of calves with Mannheimia haemolytica chimeric protein containing the major surface epitope of outer membrane lipoprotein PlpE, the neutralizing epitope of leukotoxin, and cholera toxin subunit B. Veterinary Immunology and Immunopathology, 132, 295-302.
- BABCOCK, A. H., CERNICCHIARO, N., WHITE, B. J., DUBNICKA, S. R., THOMSON, D. U., IVES, S. E., SCOTT, H. M., MILLIKEN, G. A. & RENTER, D. G., 2013. A multivariable assessment quantifying effects of cohort-level factors associated with combined mortality and culling risk in cohorts of U.S. commercial feedlot cattle. Preventive Veterinary Medicine, 108, 38-46.
- BABCOCK, A. H., RENTER, D. G., WHITE, B. J., DUBNICKA, S. R. & SCOTT, H. M., 2010. Temporal distributions of respiratory disease events within cohorts of feedlot cattle and associations with cattle health and performance indices. Preventive Veterinary Medicine, 97, 198-219.
- BABIUK, L. & CAMPOS, M., 1993. Respiratory vaccines for farm animals. In: PETERS, A.R., (ed.). Vaccines for Veterinary Applications. Oxford: Butterworth Heinemann, 83-115.
- BABIUK, L. A. & ACRES, S. D., 1984. Models for bovine respiratory disease, In: LOAN, R. W., (ed.). Bovine Respiratory Disease. Proceedings of the North American Symposium on Bovine Respiratory Disease. Texas A&M University Press, College Station, Texas.
- BAPTISTE, K. E. & KYVSGAARD, N. C., 2017. Do antimicrobial mass medications work? A systematic review and meta-analysis of randomised clinical trials investigating antimicrobial prophylaxis or metaphylaxis against naturally occurring bovine respiratory disease. Pathogens and Disease, 75.
- BATEMAN, K. G., 1988. Efficacy of a Pasteurella haemolytica vaccine/ bacterial extract in the prevention of bovine respiratory disease in recently shipped feedlot calves. Canadian Veterinary Journal, 29, 838-839.
- BATEMAN, K. G., 1993. Antimicrobial drug use in cattle. In: PRESCOTT, J. F. & BAGGOT, J. D., (eds.). Antimicrobial therapy in Veterinary Medicine. 2nd edn. Ames, Iowa: Iowa State University Press, 456-468.
- BATEMAN, K. G., MARTIN, S. W., SHEWEN, P. E. & MENZIES, P. I., 1990. An evaluation of antimicrobial therapy for undifferentiated bovine respiratory disease. Canadian Veterinary Journal, 689-697.
- BATRA, S. A., SHANTHALINGAM, S., DONOFRIO, G., HALDORSON, G. J., CHOWDHURY, S., WHITE, S. N. & SRIKUMARAN, S., 2017. Immunization of bighorn sheep against Mannheimia haemolytica with a bovine herpesvirus 1-vectored vaccine. Vaccine, 35, 1630-1636.
- BENTLEY, O. E. & CUMMINS, J. M., 1987. Efficacy of sulbactam, a betalactamase inhibitor, combined with ampicillin, in the therapy of ampicillin-resistant pneumonic pasteurellosis in feedlot calves. Canadian Veterinary Journal, 28, 591-594.
- BINGHAM, D. P., MOORE, R. & RICHARDS, A. B., 1990. Comparison of DNA:DNA homology and enzymatic activity between Pasteurella haemolytica and related species. American Journal of Veterinary Research, 51, 1161-1166.
- BLACKALL, P. J., BOJESEN, A. M., CHRISTENSEN, H. & BISGAARD, M., 2007. Reclassification of [Pasteurella] trehalosi as Bibersteinia trehalosi gen. nov., comb. nov. Journal of Systematic and Evolutionary Microbiology, 57, 666-674.
- BLOOD, D. C. & HENDERSON, J. A., 1968. Veterinary Medicine. 3rd edn. London: Bailliere, Tindall and Cassell.
- BLOOD, D. C., RADOSTITS, O. M. & HENDERSON, J. A., 1983. Veterinary Medicine. 6th edn. London: Baillière-Tindall.
- BLOOD, D. C. & STUDDERT, V. P., 1999. Saunder’s Comprehensive Veterinary Dictionary. 2nd edn. London: W. B. Saunders.
- BOUKAHIL, I. & CZUPRYNSKI, C. J., 2016. Mannheimia haemolytica biofilm formation on bovine respiratory epithelial cells. Veterinary Microbiology, 197, 129-136.
- BOUKAHIL, I. & CZUPRYNSKI, C. J., 2018. Mutual antagonism between Mannheimia haemolytica and Pasteurella multocida when forming a biofilm on bovine bronchial epithelial cells in vitro. Veterinary Microbiology, 216, 218-222.
- BOWERSOCK, T. L., HOGENESCH, H., SUCKOW, M., GUIMOND, P., MARTIN, S., BORIE, D., TORREGROSA, S., PARK, H. & PARK, K., 1999. Oral vaccination of animals with antigens encapsulated in alginate microspheres. Vaccine, 17, 1804-1811.
- BREIDER, M. A., WALKER, R. D., HOPKINS, F. M., SCHULTZ, T. W. & BOWERSOCK, T. L., 1988. Pulmonary lesions induced by Pasteurella haemolytica in neutrophil sufficient and neutrophil deficient calves. Canadian Journal of Veterinary Research, 52, 205-209.
- BRIGGS, R. E. & FRANK, G. H., 1992. Increased elastase activity in nasal mucous associated with nasal colonization by Pasteurella haemolytica in infectious bovine rhinotracheitis virus-infected calves. American Journal of Veterinary Research, 53, 631-635.
- BRIGGS, R. E. & TATUM, F. M., 1999. New mucosal vaccine in beef cattle imparts rapid resistance to pneumonic pasteurellosis after mass-medicating on feed. Presented at the United States Animal Health Association Annual Meeting, San Diego, CA.
- BROGDEN, K. A., DEBEY, B., AUDIBERT, F., LEHMKUHL, H. & CHEDID, L., 1995. Protection of ruminants by Pasteurella haemolytica S1capsular polysaccharide vaccines containing muramyl dipeptide analogs. Vaccine, 13, 1677-1684.
- CARTER, G. R., 1967. Pasteurellosis: Pasteurella multocida and Pasteurella haemolytica. Advances in Veterinary Science, 11, 321-379.
- CASWELL, J. L. & WILLIAMS, K. J., 2016. Respiratory system. In: MAXIE, M. G., (ed.). Jubb, Kennedy, and Palmer's Pathology of Domestic Animals. 6th edn. St. Louis, Missouri, USA: Elsevier.
- CHAE, C. H., GENTRY, M. J., CONFER, A. W. & ANDERSON, G. A., 1990. Resistance to host immune defense mechanisms afforded by capsular material of Pasteurella haemolytica, serotype 1. Veterinary Microbiology, 25, 241-251.
- CHANG, Y. F., RENSHAW, H. W., MARTENS, R. J. & LIVINGSTON, C. W. J., 1986. Pasteurella haemolytica leukotoxin: Chemiluminescent responses of peripheral blood leukocytes from several different mammalian species to leukotoxin- and opsonin-treated living and killed Pasteurella haemolytica and Staphylococcus aureus. American Journal of Veterinary Research, 47, 67–74.
- CHENGAPPA, M. M., MCLAUGHLIN, B. G., KADEL, W. L., MADDUX, R. L. & GREER, S. C., 1989. Efficacy of a live Pasteurella multocida vaccine for the prevention of experimentally induced bovine pneumonic pasteurellosis. Veterinary Microbiology, 21, 147-154.
- CID, D., GARCIA-ALVAREZ, A., DOMINGUEZ, L., FERNANDEZ-GARAYZABAL, J. F. & VELA, A. I., 2019. Pasteurella multocida isolates associated with ovine pneumonia are toxigenic. Veterinary Microbiology, 232, 70-73.
- CLARKE, C. R., CONFER, A. W. & MOSIER, D. A., 1998. In vivo effect of Pasteurella haemolytica infection on bovine neutrophil morphology. American Journal of Veterinary Research, 59, 588-592.
- CLINKENBEARD, K. D., MOSIER, D. A. & CONFER, A. W., 1989. Transmembrane pore size and role of cell swelling in cytotoxicity caused by Pasteurella haemolytica leukotoxin. Infection and Immunity, 57, 420-425.
- CLINKENBEARD, K. D., MOSIER, D. A., TIMKO, A. L. & CONFER, A. W., 1989. Effects of Pasteurella haemolytica leukotoxin on cultured bovine lymphoma cells. American Journal of Veterinary Research, 50, 271-275.
- CLINKENBEARD, K. D. & UPTON, M. L., 1991. Lysis of bovine platelets by Pasteurella haemolytica leukotoxin. American Journal of Veterinary Research, 52, 453-457.
- COLE, N. A., 1985. Preconditioning calves for the feedlot. Veterinary Clinics of North America: Food Animal Practice, 1, 401-411.
- CONFER, A. W., 2009. Update on bacterial pathogenesis in BRD. Animal Health Research Reviews, 10, 145-148.
- CONFER, A. W. & AYALEW, S., 2018. Mannheimia haemolytica in bovine respiratory disease: immunogens, potential immunogens, and vaccines. Animal Health Research Reviews, 19, 79-99.
- CONFER, A. W., AYALEW, S., PANCIERA, R. J., MONTELONGO, M., WHITWORTH, L. C. & HAMMER, J. D., 2003. Immunogenicity of recombinant Mannheimia haemolytica serotype 1 outer membrane protein PlpE and augmentation of a commercial vaccine. Vaccine, 21, 2821-2829.
- CONFER, A. W., AYALEW, S., STEP, D. L., TROJAN, B. & MONTELONGO, M., 2009. Intranasal vaccination of young Holstein calves with Mannheimia haemolytica chimeric protein PlpE-LKT (SAC89) and cholera toxin. Veterinary Immunology and Immunopathology, 132, 232-236.
- CONFER, A. W., FULTON, R. W., CLINKENBEARD, K. D. & DRISKEL, B. A., 1998. Duration of serum antibody responses following vaccination and revaccination of cattle with non-living commercial Pasteurella haemolytica vaccines. Vaccine, 16(20), 1962-1970.
- CONFER, A. W., PANCIERA, R. J., CLINKENBEARD, K. D. & MOSIER, D. A., 1990. Molecular aspects of virulence of Pasteurella haemolytica. Canadian Journal of Veterinary Research, 54, S48-S52.
- CONFER, A. W., PANCIERA, R. J. & MOSIER, D. A., 1988. Bovine pneumonic pasteurellosis: Immunity to Pasteurella haemolytica. Journal of the American Veterinary Medical Association, 193, 1308-1316.
- CONFER, A. W. & SIMONS, K. R., 1986. Effects of Pasteurella haemolytica lipopolysaccharide on selected functions of bovine leukocytes. American Journal of Veterinary Research, 47, 154-157.
- CONFER, A. W., SIMONS, K. R., PANCIERA, R. J., MORT, A. J. & MOSIER, D. A., 1989. Serum antibody response to carbohydrate antigens of Pasteurella haemolytica serotype 1: Relation to experimentally induced bovine pneumonic pasteurellosis. American Journal of Veterinary Research, 50, 98-105.
- CONLON, J. A., GALLO, G. F., SHEWEN, P. E. & ADLAM, C., 1995. Comparison of protection of experimentally challenged cattle vaccinated once or twice with a Pasteurella haemolytica bacterial extract vaccine. Canadian Journal of Veterinary Research, 59, 179-182.
- CONLON, J. A. & SHEWEN, P. E., 1993. Clinical and serological evaluation of a Pasteurella haemolytica S1capsular polysaccharide vaccine. Vaccine, 11, 767-772.
- COONEY, B. J. & LO, R. Y., 1993. Three contiguous lipoprotein genes in Pasteurella haemolytica S1which are homologous to a lipoprotein gene in Haemophilus influenzae type b. Infection and Immunity, 61, 4682-4688.
- CZUPRYNSKI, C. J., NOEL, E. F. & ADLAM, C., 1989. Modulation of bovine neutrophil antibacterial activities by Pasteurella haemolytica S1purified capsular polysaccharide. Microbial Pathogenesis, 6, 133-141.
- DABO, S. M., CONFER, A., MONTELONGO, M., YORK, P. & WYCKOFF, J. H., 3RD., 2008. Vaccination with Pasteurella multocida recombinant OmpA induces strong but non-protective and deleterious Th2-type immune response in mice. Vaccine, 26, 4345-4351.
- DABO, S. M., CONFER, A. W. & MURPHY, G. L., 1997. Outer membrane proteins of bovine Pasteurella multocida serogroup A isolates. Veterinary Microbiology, 54, 167-183.
- DABO, S. M., CONFER, A. W. & QUIJANO-BLAS, R. A., 2003. Molecular and immunological characterization of Pasteurella multocida serotype A:3 OmpA: evidence of its role in P. multocida interaction with extracellular matrix molecules. Microbial Pathogenesis, 35, 147-157.
- DABO, S. M., TAYLOR, J. D. & CONFER, A. W., 2007. Pasteurella multocida and bovine respiratory disease. Animal Health Research Reviews, 8, 129-150.
- DAGLEISH, M. P., BAYNE, C. W., MOON, G. G., FINLAYSON, J., SALES, J., WILLIAMS, J. & HODGSON, J. C., 2016. Differences in Virulence Between Bovine-Derived Clinical Isolates of Pasteurella multocida Serotype A from the UK and the USA in a Model of Bovine Pneumonic Pasteurellosis. Journal of Comparative Pathology, 155, 62-71.
- DAGLEISH, M. P., FINLAYSON, J., BAYNE, C., MACDONALD, S., SALES, J. & HODGSON, J. C., 2010. Characterization and time course of pulmonary lesions in calves after intratracheal infection with Pasteurella multocida A:3. Journal of Comparative Pathology, 142, 157-169.
- DEDONDER, K. D. & APLEY, M. D., 2015a. A literature review of antimicrobial resistance in Pathogens associated with bovine respiratory disease. Animal Health Research Reviews, 16, 125-134.
- DEDONDER, K. D. & APLEY, M. D., 2015b. A review of the expected effects of antimicrobials in bovine respiratory disease treatment and control using outcomes from published randomized clinical trials with negative controls. Veterinary Clinics of North America: Food Animal Practice, 31, 97-111, vi.
- DONACHIE, W., 1999. Cattle Pasteurellosis Vaccine. Moredun Research Institute Annual Report for 1999, 10.
- EARLEY, B., BUCKHAM SPORER, K. & GUPTA, S., 2017. Invited review: Relationship between cattle transport, immunity and respiratory disease. Animal, 11, 486-492.
- ENGELKEN, T. J., 1997. Preventive programs for respiratory disease in cow/calf operations. Veterinary Clinics of North America: Food Animal Practice, 13, 647-660.
- EWERS, C., LUBKE-BECKER, A., BETHE, A., KIEBLING, S., FILTER, M. & WIELER, L. H., 2006. Virulence genotype of Pasteurella multocida strains isolated from different hosts with various disease status. Veterinary Microbiology, 114, 304-317.
- FAJT, V. R., APLEY, M. D., BROGDEN, K. A., SKOGERBOE, T. L., SHOSTROM, V. K. & CHIN, Y. L., 2004. Effect of danofloxacin and tilmicosin on body temperatures of beef calves with pneumonia experimentally induced by inoculation with Mannheimia haemolytica. American Journal of Veterinary Research, 65, 610-615.
- FARLEY, H., 1932. An epizoological study of shipping fever in Kansas. Journal of the American Veterinary Medical Association, 52, 165-172.
- FILION, L. G., WILLSON, P. J., BIELEFELDT-OHMANN, H., BABIUK, L. A. & THOMSON, R. G., 1984. The possible role of stress in the induction of pneumonic pasteurellosis. Canadian Journal of Comparative Medicine, 48, 268-274.
- FRANCOZ, D., BUCZINSKI, S., BELANGER, A. M., FORTE, G., LABRECQUE, O., TREMBLAY, D., WELLEMANS, V. & DUBUC, J., 2015. Respiratory pathogens in Quebec dairy calves and their relationship with clinical status, lung consolidation, and average daily gain. Journal of Veterinary Internal Medicine, 29, 381-387.
- FRANK, G. H., 1984. Bacteria as etiologic agents in bovine respiratory disease. In: LOAN, R. W., (ed.). Bovine Respiratory Disease. College Station, Texas: Texas A&M University Press.
- FRANK, G. H., 1989. Pasteurellosis of cattle. In: ADLAM, C. & RUTTER, J. M., (eds). Pasteurella and Pasteurellosis. London: Academic Press.
- FRANK, G. H. & BRIGGS, R. E., 1992. Colonization of the tonsils of calves with Pasteurella haemolytica. American Journal of Veterinary Research, 53, 481-484.
- FRANK, G. H., BRIGGS, R. E., DUFF, G. C., LOAN, R. W. & PURDY, C. W., 2002. Effects of vaccination prior to transit and administration of florfenicol at time of arrival in a feedlot on the health of transported calves and detection of Mannheimia haemolytica in nasal secretions. American Journal of Veterinary Research, 63, 251-256.
- FRANK, G. H., BRIGGS, R. E. & GILLETTE, K. G., 1987. Pasteurella haemolytica serotype 1 colonization of the nasal passages of virus-infected calves. American Journal of Veterinary Research, 48, 1674-1677.
- FRANK, G. H., BRIGGS, R. E., LOAN, R. W., PURDY, C. W. & ZEHR, E. S., 1994. Serotype-specific inhibition of colonization of the tonsils and nasopharynx of calves after Pasteurella haemolytica serotype S1after vaccination with the organism. American Journal of Veterinary Research, 55, 1107-1110.
- FRANK, G. H., BRIGGS, R. E. & ZEHR, E. S., 1995. Colonization of the tonsils and nasopharynx of calves by a rifampicin-resistant Pasteurella haemolytica and its inhibition by vaccination. American Journal of Veterinary Research, 56, 866-869.
- FRANK, G. H. & SMITH, P. C., 1983. Prevalence of Pasteurella haemolytica in transported calves. American Journal of Veterinary Research, 44, 981-985.
- FRANK, G. H. & TABATABAI, L. B., 1981. Neuraminidase activity of Pasteurella haemolytica isolates. Infection and Immunity, 32, 1119-1122.
- FRANK, G. H. & WESSMAN, G. E., 1978. Rapid plate agglutination procedure for serotyping Pasteurella haemolytica. Journal of Clinical Microbiology, 7, 142-145.
- FRIEND, S. C., THOMSON, R. G. & WILKIE, B. N., 1977. Pulmonary lesions induced by Pasteurella haemolytica in cattle. Canadian Journal of Comparative Medicine, 41, 219-222.
- FRIEND, S. C., WILKIE, B. N., THOMSON, R. G. & BARNUM, D. A., 1977. Bovine pneumonic pasteurellosis: Experimental induction in vaccinated and nonvaccinated calves. Canadian Journal of Comparative Medicine, 41, 77-83.
- FULTON, R. W., BLOOD, K. S., PANCIERA, R. J., PAYTON, M. E., RIDPATH, J. F., CONFER, A. W., SALIKI, J. T., BURGE, L. T., WELSH, R. D., JOHNSON, B. J. & RECK, A., 2009. Lung pathology and infectious agents in fatal feedlot pneumonias and relationship with mortality, disease onset, and treatments. Journal of Veterinary Diagnostic Investigation, 21, 464-477.
- GAETA, N. C., LIMA, S. F., TEIXEIRA, A. G., GANDA, E. K., OIKONOMOU, G., GREGORY, L. & BICALHO, R. C., 2017. Deciphering upper respiratory tract microbiota complexity in healthy calves and calves that develop respiratory disease using shotgun metagenomics. Journal of Dairy Science, 100, 1445-1458.
- GALDIERO, M., PISCIOTTA, M. G., MARINELLI, A., PETRILLO, G. & GALDIERO, E., 2002. Coinfection with BoHV modulates cell adhesion and invasion by P. multocida and Mannheimia (Pasteurella) haemolytica. New Microbiologica, 25, 427-436.
- GATEWOOD, D. M., FENWICK, B. W. & CHENGAPPA, M. M., 1994. Growth-condition dependent expression of Pasteurella haemolytica S1outer membrane proteins, capsule, and leukotoxin. Veterinary Microbiology, 41, 221-233.
- GATTO, N. T., DABO, S. M., HANCOCK, R. E. & CONFER, A. W., 2002. Characterization of, and immune responses of mice to, the purified OmpA-equivalent outer membrane protein of Pasteurella multocida serotype A:3 (Omp28). Veterinary Microbiology, 87, 221-235.
- GENTRY, M. J., CONFER, A. W. & PANCIERA, R. J., 1985. Serum neutralization of cytotoxin from Pasteurella haemolytica, serotype 1 and resistance to experimental bovine pneumonic pasteurellosis. Veterinary Immunology and Immunopathology, 9, 239-250.
- GESCHWEND, G., FEIST, H. & ERLER, W., 1997. Investigation of outer membrane proteins of Pasteurella. 2: Iron-regulated outer membrane proteins of Pasteurella multocida and Pasteurella haemolytica. Berliner und Münchener Tierärztliche Wochenschrift, 110, 386-390.
- GIBBS, H. A., ALLAN, E. M., WISEMAN, A. & SELMAN, I. E., 1984. Experimental production of bovine pneumonic pasteurellosis. Research in Veterinary Science, 37, 154-166.
- GILMOUR, N. J., DONACHIE, W., SUTHERLAND, A. D., GILMOUR, J. S., JONES, G. E. & QUIRIE, M., 1991. Vaccine containing iron-regulated proteins of Pasteurella haemolytica A2 enhances protection against experimental pasteurellosis in lambs. Vaccine, 9, 137-140.
- GONZALEZ-RAYOS, C., LO, R. Y., SHEWEN, P. E. & BEVERIDGE, T. J., 1986. Cloning of a serotype-specific antigen from Pasteurella haemolytica A1. Infection and Immunity, 53, 505-510.
- GORHAM, P. E., CARROLL, L. H., MCASKILL, J. W., WATKINS, L. E., OSE, E. E., TONKINSON, L. V. & MERRILL, J. K., 1990. Tilmicosin as a single injection treatment for respiratory disease of feedlot cattle. Canadian Veterinary Journal, 31, 826-829.
- GOURLAY, R. N. & HOUGHTON, S. B., 1985. Experimental pneumonia in conventionally reared and gnotobiotic calves by dual infection with Mycoplasma bovis and Pasteurella haemolytica. Research in Veterinary Science, 38, 377-382.
- GREY, C. L. & THOMSON, R. G., 1971. Pasteurella haemolytica in the tracheal air of calves. Canadian Journal of Comparative Medicine, 35, 121-128.
- GRIFFIN, C. M., SCOTT, J. A., KARISCH, B. B., WOOLUMS, A. R., BLANTON, J. R., KAPLAN, R. M., EPPERSON, W. B. & SMITH, D. R., 2018. A randomized controlled trial to test the effect of on-arrival vaccination and deworming on stocker cattle health and growth performance. Bovine Practitioner, 52, 26-33.
- GRIFFIN, D., 1998. Feedlot diseases. Veterinary Clinics of North America: Food Animal Practice, 14, 199-231.
- GRISSETT, G. P., WHITE, B. J. & LARSON, R. L., 2015. Structured literature review of responses of cattle to viral and bacterial pathogens causing bovine respiratory disease complex. Journal of Veterinary Internal Medicine, 29, 770-780.
- HAMDY, A. H., KING, N. B. & TRAPP, A. L., 1965. Attempted immunization of cattle against shipping fever: A field trial. American Journal of Veterinary Research, 26, 897-902.
- HARLAND, R. J., JIM, G. K., GUICHON, P. T., TOWNSEND, H. G. G. & JANZEN, E. D., 1991. Efficacy of parenteral antibiotics for disease prophylaxis in feedlot calves. Canadian Veterinary Journal, 32, 163-168.
- HARLAND, R. J., MCCARTNEY, D. H. & POTTER, A. P., 1992. Evaluation of P. haemolytica vaccination strategies in beef calves. (Abstract 93). Proceedings of the 73rd Conference of Research Workers in Animal Disease, Chicago, IL.
- HARLAND, R. J., POTTER, A. A., VAN DRUNEN-LITTEL-VAN DEN HURK, S., VAN DONKERSGOED, J., PARKER, M. D., ZAMB, T. J. & JANZEN, E. D., 1992. The effect of subunit or modified live bovine herpesvirus-1 vaccines on the efficacy of a recombinant Pasteurella haemolytica vaccine for the prevention of respiratory disease in feedlot calves. Canadian Veterinary Journal, 33, 734-741.
- HARPER, M. & BOYCE, J. D., 2017. The Myriad Properties of Pasteurella multocida Lipopolysaccharide. Toxins (Basel), 9.
- HARPER, M., BOYCE, J. D. & ADLER, B., 2006. Pasteurella multocida pathogenesis: 125 years after Pasteur. FEMS Microbiology Letters, 265, 1-10.
- HENTSCHL, A. F., 1987. Is preconditioning doomed to fail? A Michigan practitioner’s viewpoint. Bovine Proceedings, 19, 185-187.
- HIBBARD, B., ROBB, E. J., CHESTER, S. T., JR., DAME, K. J., BOUCHER, J. F. & ALANIZ, G. R., 2002a. Dose determination and confirmation of a long-acting formulation of ceftiofur (ceftiofur crystalline free acid) administered subcutaneously for the treatment of bovine respiratory disease. Journal of Veterinary Pharmacology and Therapeutics, 25, 175-180.
- HIBBARD, B., ROBB, E. J., CHESTER, S. T., JR., DAME, K. J., MOSELEY, W. W. & BRYSON, W. L., 2002b. Dose determination and confirmation for ceftiofur crystalline-free acid administered in the posterior aspect of the ear for control and treatment of bovine respiratory disease. Veterinary Therapeutics, 3, 22-30.
- HILTON, W. M. & OLYNK, N. J., 2011. Profitability of preconditioning: lessons learned from an 11-year case study of an Indiana beef herd. Bovine Practitioner, 45, 40-50.
- HIRSH, D., 1999. Veterinary Microbiology. Boston: Blackwell Scientific Publications, 135-140.
- HJERPE, C. A., 1990. Bovine vaccines and herd vaccination programs. Veterinary Clinics of North America, Food Animal Practice, 6, 171-260.
- HOAR, B. R., JELINSKI, M. D., RIBBLE, C. S., JANZEN, E. D. & JOHNSON, J. C., 1998. A comparison of the clinical field efficacy and safety of florfenicol and tilmicosin for the treatment of undifferentiated bovine respiratory disease of cattle in western Canada. Canadian Veterinary Journal, 39, 161-166.
- HODGINS, D. C. & SHEWEN, P. E., 1992. Immunity to Pasteurella haemolytica in replacement dairy heifers. 12th International Symposium of the World Association of Veterinary Microbiologists, Immunologists and Specialists in Infectious Diseases, Davis, California.
- HODGINS, D. C. & SHEWEN, P. E., 1998. Serologic responses of young colostrum fed dairy calves to antigens of Pasteurella haemolytica A1. Vaccine, 16, 2018-2025.
- HOLMAN, D. B., TIMSIT, E., AMAT, S., ABBOTT, D. W., BURET, A. G. & ALEXANDER, T. W., 2017. The nasopharyngeal microbiota of beef cattle before and after transport to a feedlot. BMC Microbiology, 17, 70.
- HOLMAN, D. B., TIMSIT, E., BOOKER, C. W. & ALEXANDER, T. W., 2018. Injectable antimicrobials in commercial feedlot cattle and their effect on the nasopharyngeal microbiota and antimicrobial resistance. Veterinary Microbiology, 214, 140-147.
- JARAMILLO, L., DIAZ, F., HERNANDEZ, P., DEBRAY, H., TRIGO, F., MENDOZA, G. & ZENTENO, E., 2000. Purification and characterization of an adhesin from Pasteurella haemolytica. Glycobiology, 10, 31-37.
- JENSEN, R., PIERSON, R. E., BRADDY, P. M., SAARI, D. A., LAUERMAN, L. H., ENGLAND, J. J., KEYVANFAR, H., COLLIER, J. R., HORTON, D. P., MCCHESNEY, A. E., BENITEZ, A. & CHRISTIE, R. M., 1976. Shipping fever pneumonia in yearling feedlot cattle. Journal of the American Veterinary Medical Association, 169, 500-506.
- JERICHO, K. W., CHO, H. J. & KOZUB, G. C., 1990. Protective effect of inactivated Pasteurella haemolytica bacterin challenged in bovine herpesvirus-1 experimentally infected calves. Vaccine, 8, 315-320.
- JERICHO, K. W., LOEWEN, K. G., SMITHSON, S. E. & KOZUB, G. C., 1991. Protective effect of inactivated bovine herpesvirus-1 in calves experimentally infected with bovine herpesvirus-1 and Pasteurella haemolytica. Research in Veterinary Science, 51, 209-214.
- JERICHO, K. W. F., 1979. Update on pasteurellosis in young cattle. Canadian Veterinary Journal, 20, 333-335.
- JERICHO, K. W. F., 1989. Efficacy of a Pasteurella haemolytica vaccine/ bacterial extract. Canadian Veterinary Journal, 30, 287.
- JERICHO, K. W. F. & LANGFORD, E. V., 1978. Pneumonia in calves produced with aerosols of bovine herpesvirus-1 and Pasteurella haemolytica. Canadian Journal of Comparative Medicine, 42, 269-277.
- JIM, G. K., BOOKER, C. W., GUICHON, P. T., SCHUNICHT, O. C., WILDMAN, B. K., JOHNSON, J. C. & LOCKWOOD, P. W., 1999. A comparison of florfenicol and tilmicosin for the treatment of undifferentiated fever in feedlot calves in western Canada. Canadian Veterinary Journal, 40, 179-184.
- JIM, G. K. & GUICHON, P. T., 1989. Assessing the value of preconditioning to feedlots. Bovine Proceedings, 21, 90-91.
- JIM, G. K. & GUICHON, P. T., 1990. Criticism of Alberta preconditioned feeder review. Canadian Veterinary Journal, 31, 158-160.
- JIM, K., GUICHON, T. & SHAW, G., 1988. Protecting calves from pneumonic pasteurellosis. Veterinary Medicine, 83, 1084-1087.
- JOHNSON, K. K. & PENDELL, D. L., 2017. Market Impacts of Reducing the Prevalence of Bovine Respiratory Disease in United States Beef Cattle Feedlots. Frontiers in Veterinary Science, 4, 189.
- JONES, C. D. R., 1987. Proliferation of Pasteurella haemolytica in the respiratory tract after an abrupt change in climate. Research in Veterinary Science, 42, 179-186.
- JORDAN, T., 1987. Preconditioning of calves from the feedyard perspective. Bovine Proceedings, 19, 182-184.
- JUBB, K. V. F. & KENNEDY, P. C., 1970. Pathology of Domestic Animals. 2nd edn. New York: Academic Press.
- JUBB, K. V. F., KENNEDY, P. C. & PALMER, N., 1993. Pathology of Domestic Animals. 2nd edn. San Diego: Academic Press.
- KAEHLER, K. L., MARKHAM, R. J. F., MUSCOPLAT, C. C. & JOHNSON, D. W., 1980. Evidence of species specificity in the cytocidal effects of Pasteurella haemolytica. Infection and Immunity, 30, 615-616.
- KARREN, D. B., BASARAB, J. A. & CHURCH, T. L., 1987. The growth and economic performance of preconditioned calves and their dams on the farm and of calves in the feedlot. Canadian Journal of Animal Science, 67, 327-336.
- KATSUDA, K., KAMIYAMA, M., KOHMOTO, M., KAWASHIMA, K., TSUNEMITSU, H. & EGUCHI, M., 2008. Serotyping of Mannheimia haemolytica isolates from bovine pneumonia: 1987-2006. Veterinary Journal, 178, 146-148.
- KATSUDA, K., KOHMOTO, M. & MIKAMI, O., 2013. Relationship between serotype and the antimicrobial susceptibility of Mannheimia haemolytica isolates collected between 1991 and 2010. Research in Veterinary Science, 94, 205-208.
- KELLY, A. P. & JANZEN, E. D., 1986. A review of morbidity and mortality rates and disease occurrence in North American feedlot cattle. Canadian Veterinary Journal, 27, 496-500.
- KILGORE, W. R., SPENSLEY, M. S., SUN, F., NUTSCH, R. G., ROONEY, K. A. & SKOGERBOE, T. L., 2005a. Clinical effectiveness of tulathromycin, a novel triamilide antimicrobial, for the control of respiratory disease in cattle at high risk for developing bovine respiratory disease. Veterinary Therapeutics, 6, 136-142.
- KILGORE, W. R., SPENSLEY, M. S., SUN, F., NUTSCH, R. G., ROONEY, K. A. & SKOGERBOE, T. L., 2005b. Therapeutic efficacy of tulathromycin, a novel triamilide antimicrobial, against bovine respiratory disease in feeder calves. Veterinary Therapeutics, 6, 143-153.
- KIMMAN, T. G., WESTENBRINK, F. & STRAVER, P. J., 1989. Priming for local and systemic antibody memory responses to bovine respiratory syncytial virus: effect of amount of virus, virus replication, route of administration and maternal antibodies. Veterinary Immunology and Immunopathology, 22, 145-160.
- KIORPES, A. L., BUTLER, D. G., DUBIELZIG, R. R. & BECK, K. A., 1988. Enzootic pneumonia in calves: Clinical and morphological features. Compendium for the Continuing Education of the Practicing Veterinarian, 10, 248-260.
- KISIELA, D. I. & CZUPRYNSKI, C. J., 2009. Identification of Mannheimia haemolytica adhesins involved in binding to bovine bronchial epithelial cells. Infection and Immunity, 77, 446-455.
- KLIMA, C. L., ALEXANDER, T. W., HENDRICK, S. & MCALLISTER, T. A., 2014. Characterization of Mannheimia haemolytica isolated from feedlot cattle that were healthy or treated for bovine respiratory disease. Canadian Journal of Veterinary Research, 78, 38-45.
- KLIMA, C. L., ALEXANDER, T. W., READ, R. R., GOW, S. P., BOOKER, C. W., HANNON, S., SHEEDY, C., MCALLISTER, T. A. & SELINGER, L. B., 2011. Genetic characterization and antimicrobial susceptibility of Mannheimia haemolytica isolated from the nasopharynx of feedlot cattle. Veterinary Microbiology, 149, 390-398.
- KUMAR, J., DIXIT, S. K. & KUMAR, R., 2015. Rapid detection of Mannheimia haemolytica in lung tissues of sheep and from bacterial culture. Veterinary World, 8, 1073-1077.
- LAMM, C. G., LOVE, B. C., KREHBIEL, C. R., JOHNSON, N. J. & STEP, D. L., 2012. Comparison of antemortem antimicrobial treatment regimens to antimicrobial susceptibility patterns of postmortem lung isolates from feedlot cattle with bronchopneumonia. Journal of Veterinary Diagnostic Investigation, 24, 277-282.
- LARSON, R. L. & STEP, D. L., 2012. Evidence-based effectiveness of vaccination against Mannheimia haemolytica, Pasteurella multocida, and Histophilus somni in feedlot cattle for mitigating the incidence and effect of bovine respiratory disease complex. Veterinary Clinics of North America: Food Animal Practice, 28(1), 97-106.
- LEE, C. W. & SHEWEN, P. E., 1996. Evidence of bovine immunoglobulin G1 (IgG1) protease activity in partially purified culture supernate of Pasteurella haemolytica A1. Canadian Journal of Veterinary Research, 60, 127-132.
- LEE, C. W., SHEWEN, P. E., CLADMAN, W. M., CONLON, J. A., MELLORS, A. & LO, R. Y., 1994. Sialoglycoprotease of Pasteurella haemolytica A1: Detection of antisialoglycoprotease antibodies in sera of calves. Canadian Journal of Veterinary Research, 58, 93-98.
- LEITE, F., MALAZDREWICH, C., YOO, H. S., MAHESWARAN, S. K. & CZUPRYNSKI, C. J., 1999. Use of TUNEL staining to detect apoptotic cells in the lungs of cattle experimentally infected with Pasteurella haemolytica. Microbial Pathogenesis, 27, 179-185.
- LIBERSA, H., VAN HUFFEL, B. & MADELENAT, A., 1995. Evaluation of the efficacy of a new antibiotic, florfenicol (Nuflor) in the treatment of bovine respiratory disease. Recueil de Medecine Veterinaire, 171, 39-44.
- LILLIE, L. E. & THOMSON, R. G., 1972. The pulmonary clearance of bacteria by calves and mice. Canadian Journal of Comparative Medicine, 36, 129-137.
- LIN, X. Q., O’REILLY, K. L., STORZ, J., PURDY, C. W. & LOAN, R. W., 1999. Humoral immune response of cattle to respiratory bovine coronavirus (RBCV) antigens in shipping fever. Proceedings of the 80th Annual Meeting of the Conference of Research Workers in Animal Disease, Chicago, IL.
- LINHART, R. D. & BRUMBAUGH, G. W., 2019. Control of bovine respiratory disease, with and without co-morbidity by otitis media, in dairy heifers comparing gamithromycin, tulathromycin, or no medication at a commercial development facility. Journal of Dairy Science, 102, 5501-5510.
- LO, R. Y., STRATHDEE, C. A., SHEWEN, P. E. & COONEY, B. J., 1991. Molecular studies of Ssa1, a serotype-specific antigen of Pasteurella haemolytica A1. Infection and Immunity, 59, 3398-3406.
- LONERAGAN, G. H., DARGATZ, D. A., MORLEY, P. S. & SMITH, M. A., 2001. Trends in mortality ratios among cattle in US feedlots. Journal of the American Veterinary Medical Association, 219, 1122-1127.
- LOPEZ, A., MAXIE, M. G., SAVAN, M., RUHNKE, H. L., THOMSON, R. G., BARNUM, D. A. & GEISSINGER, H. D., 1982. The pulmonary clearance of Pasteurella haemolytica in calves infected with bovine virus diarrhea or Mycoplasma bovis. Canadian Journal of Comparative Medicine, 46, 302-306.
- LOPEZ, A., THOMSON, R. G. & SAVAN, M., 1976. The pulmonary clearance of Pasteurella haemolyticain calves infected with bovine parainfluenza 3 virus. Canadian Journal of Comparative Medicine, 40, 385-391.
- LOY, J. D., LEGER, L., WORKMAN, A. M., CLAWSON, M. L., BULUT, E. & WANG, B., 2018. Development of a multiplex real-time PCR assay using two thermocycling platforms for detection of major bacterial pathogens associated with bovine respiratory disease complex from clinical samples. Journal of Veterinary Diagnostic Investigation, 30, 837-847.
- MACGREGOR, S., SMITH, D., PERINO, L. & HUNSAKER, B., 2003. An evaluation of the effectiveness of a commercial Mannheimia (Pasteurella) haemolytica vaccine in a commercial feedlot. Bovine Practitioner, 37, 78-82.
- MAGSTADT, D. R., SCHULER, A. M., COETZEE, J. F., KRULL, A. C., O'CONNOR, A. M., COOPER, V. L. & ENGELKEN, T. J., 2018. Treatment history and antimicrobial susceptibility results for Mannheimia haemolytica, Pasteurella multocida, and Histophilus somni isolates from bovine respiratory disease cases submitted to the Iowa State University Veterinary Diagnostic Laboratory from 2013 to 2015. Journal of Veterinary Diagnostic Investigation, 30, 99-104.
- MAHASRESHTI, P. J., MURPHY, G. L., WYCKOFF, J. H. R., FARMER, S., HANCOCK, R. E. & CONFER, A. W., 1997. Purification and partial characterization of the OmpA family of proteins of Pasteurella haemolytica. Infection and Immunity, 65, 211-218.
- MAHESWARAN, S. K. & THIES, E. S., 1979. Influence of encapsulation on phagocytosis of Pasteurella multocida by bovine neutrophils. Infection and Immunity, 26, 76-81.
- MAJURY, A. L. & SHEWEN, P. E., 1991. The effect of Pasteurella haemolytica S1leukotoxic culture supernate on the in vitro proliferative response of bovine lymphocytes. Veterinary Immunology and Immunopathology, 29, 41-56.
- MARTIN, S. W., 1983. Vaccination: Is it effective in preventing respiratory disease or influencing weight gains in feedlot calves? Canadian Veterinary Journal, 24, 10-19.
- MARTIN, S. W., MEEK, A. H., DAVIS, D. G., JOHNSON, J. A. & CURTIS, R. A., 1981. Factors associated with morbidity and mortality in feedlot calves: The Bruce County Beef Project, Year Two. Canadian Journal of Comparative Medicine, 45, 103-112.
- MARTIN, S. W., MEEK, A. H., DAVIS, D. G., THOMSON, R. G., JOHNSON, J. A., LOPEZ, A., STEPHANS, L., CURTIS, R. A., PRESCOTT, J. F., ROSENDAL, S., SAVAN, M., ZUBAIDY, A. J. & BOLTON, M. R., 1980. Factors associated with mortality in feedlot cattle: The Bruce County Beef Cattle Project. Canadian Journal of Comparative Medicine, 44, 1-10.
- MCDANELD, T. G., KUEHN, L. A. & KEELE, J. W., 2018. Evaluating the microbiome of two sampling locations in the nasal cavity of cattle with bovine respiratory disease complex (BRDC). Journal of Animal Science.
- MCMULLEN, C., ORSEL, K., ALEXANDER, T. W., VAN DER MEER, F., PLASTOW, G. & TIMSIT, E., 2018. Evolution of the nasopharyngeal bacterial microbiota of beef calves from spring processing to 40 days after feedlot arrival. Veterinary Microbiology, 225, 139-148.
- MCMULLEN, C., ORSEL, K., ALEXANDER, T. W., VAN DER MEER, F., PLASTOW, G. & TIMSIT, E., 2019. Comparison of the nasopharyngeal bacterial microbiota of beef calves raised without the use of antimicrobials between healthy calves and those diagnosed with bovine respiratory disease. Veterninary Microbiology, 231, 56-62.
- MECHOR, G. D., JIM, G. K. & JANZEN, E. D., 1988. Comparison of penicillin, oxytetracycline, and trimethoprim-sulfadoxine in the treatment of acute undifferentiated bovine respiratory disease. Canadian Veterinary Journal, 29, 438-443.
- MILES, D. G., 2009. Overview of the North American beef cattle industry and the incidence of bovine respiratory disease (BRD). Animal Health Research Reviews, 10, 101-103.
- MILES, D. G. & ROGERS, K. C., 2014. BRD control: tying it all together to deliver value to the industry. Animal Health Research Reviews, 15, 186-188.
- MILLER, A. W., HOWARD, L. H., BAYARD, E. S., SMITH, R. W., STANARD, S. J., JONES, J. D., HILTON, G., KILLHAM, B. J. & TRUAM, J., 1927. Report of committee on miscellaneous transmissible diseases. Journal of the American Veterinary Medical Association, 70, 952-955.
- MOISA, S. J., ALY, S. S., LEHENBAUER, T. W., LOVE, W. J., ROSSITTO, P. V., VAN EENENNAAM, A. L., TROMBETTA, S. C., BORTOLUZZI, E. M. & HULBERT, L. E., 2019. Association of plasma haptoglobin concentration and other biomarkers with bovine respiratory disease status in pre-weaned dairy calves. Journal of Veterinary Diagnostic Investigation, 31, 40-46.
- MOORE, D. P., HODGINS, D. C., FIRTH, M. A., MCBEY, B. A. & SHEWEN, P. E., 2011. Incorporation of antigens from Mannheimia haemolytic culture supernatant, and recombinant bovine C3d into ISCOM matrix using neutravidin-biotin interaction. Biotechnology and Applied Biochemistry, 58, 198-202.
- MOORE, S. J., O'DEA, M. A., PERKINS, N., BARNES, A. & O'HARA, A. J., 2014. Mortality of live export cattle on long-haul voyages: pathologic changes and pathogens. Journal of Veterinary Diagnostic Investigation, 26, 252-265.
- MORCK, D. W., ELLIS, B. D., DOMINGUE, P. A., OLSON, M. E. & COSTERTON, J. W., 1991. In vivo expression of iron regulated outer-membrane proteins in Pasteurella haemolytica-A1. Microbial Pathogenesis, 11, 373-378.
- MORCK, D. W., OLSON, M. E., ACRES, S. D., DAOUST, P. Y. & COSTERTON, J. W., 1989. Presence of bacterial glycocalyx and fimbriae on Pasteurella haemolytica in feedlot cattle with pneumonic pasteurellosis. Canadian Journal of Veterinary Research, 53, 167-171.
- MORCK, D. W., RAYBOULD, T. J., ACRES, S. D., BABIUK, L. A., NELLIGAN, J. & COSTERTON, J. W., 1987. Electron microscopic description of glycocalyx and fimbriae on the surface of Pasteurella haemolytica-A1. Canadian Journal of Veterinary Research, 51, 83-88.
- MORCK, D. W., WATTS, T. C., ACRES, S. D. & COSTERTON, J. W., 1988. Electron microscopic examination of cells of Pasteurella haemolytica S1in experimentally infected cattle. Canadian Journal of Veterinary Research, 52, 343-348.
- MOSIER, D. A., 1997. Bacterial pneumonia. Veterinary Clinics of North America—Food Animal Practice, 13, 483-493.
- MOSIER, D. A., CONFER, A. W. & PANCIERA, R. J., 1989. The evolution of vaccines for bovine pneumonic pasteurellosis. Research in Veterinary Science, 47, 1-10.
- MOSIER, D. A., PANCIERA, R. J., ROGERS, D. P., UHLICH, G. A., BUTINE, M. D., CONFER, A. W. & BASARABA, R. J., 1998. Comparison of serologic and protective responses induced by two Pasteurella vaccines. Canadian Journal of Veterinary Research, 62, 178-182.
- MURRAY, G. M., MORE, S. J., SAMMIN, D., CASEY, M. J., MCELROY, M. C., O'NEILL, R. G., BYRNE, W. J., EARLEY, B., CLEGG, T. A., BALL, H., BELL, C. J. & CASSIDY, J. P., 2017a. Pathogens, patterns of pneumonia, and epidemiologic risk factors associated with respiratory disease in recently weaned cattle in Ireland. Journal of Veterinary Diagnostic Investigation, 29, 20-34.
- MURRAY, G. M., O'NEILL, R. G., LEE, A. M., MCELROY, M. C., MORE, S. J., MONAGLE, A., EARLEY, B. & CASSIDY, J. P., 2017b. The bovine paranasal sinuses: Bacterial flora, epithelial expression of nitric oxide and potential role in the in-herd persistence of respiratory disease pathogens. PLoS One, 12, e0173845.
- MWANGOTA, A. U., MUHAMMED, S. I. & THOMSON, R. G., 1978. Serological types of Pasteurella haemolytica in Kenya. Cornell Veterinarian, 68, 84-93.
- N'JAI A, U., RIVERA, J., ATAPATTU, D. N., OWUSU-OFORI, K. & CZUPRYNSKI, C. J., 2013. Gene expression profiling of bovine bronchial epithelial cells exposed in vitro to bovine herpesvirus 1 and Mannheimia haemolytica. Veterinary Immunology and Immunopathology, 155, 182-189.
- NARDINI, P. M., MELLORS, A. & LO, R. Y., 1998. Characterization of a fourth lipoprotein from Pasteurella haemolytica S1and its homology to the OmpA family of outer membrane proteins. FEMS Microbiological Letters, 165, 71-77.
- NOYES, N. R., BENEDICT, K. M., GOW, S. P., BOOKER, C. W., HANNON, S. J., MCALLISTER, T. A. & MORLEY, P. S., 2015. Mannheimia haemolytica in feedlot cattle: prevalence of recovery and associations with antimicrobial use, resistance, and health outcomes. Journal of Veterinary Internal Medicine, 29, 705-713.
- ODENDAAL, M. W. & HENTON, M. M., 1995. The distribution of Pasteurella haemolytica serotypes among cattle, sheep, and goats in South Africa and their association with diseases. Onderstepoort Journal of Veterinary Research, 62, 223-226.
- OGUNNARIWO, J. A. & SCHRYVERS, A. B., 1990. Iron acquisition in Pasteurella haemolytica: Expression and identification of a bovine-specific transferrin receptor. Infection and Immunity, 58, 2091-2097.
- OLCHOWY, T. W. J., TERHUNE, T. N. & HERRICK, R. L., 2000. Efficacy of difloxacin in calves experimentally infected with Mannheimia haemolytica. American Journal of Veterinary Research, 61, 710-713.
- PANCIERA, R. J. & CONFER, A. W., 2010. Pathogenesis and pathology of bovine pneumonia. Veterinary Clinics of North America: Food Animal Practice, 26, 191-214.
- PANCIERA, R. J. & CORSTVET, R. E., 1984. Bovine pneumonic pasteurellosis: model for Pasteurella haemolytica and Pasteurella multocida induced pneumonia in cattle. American Journal of Veterinary Research, 45, 2532-2537.
- PARKER, W. R., WINDER, J. A., GALYEAN, M. L. & CRAVENS, R. L., 1993. Effects of vaccination at branding on serum antibody titers to viral agents of bovine respiratory disease (BRD) in newly weaned New Mexico calves. Journal of Animal Science, 71(1), 121.
- PERIASAMY, S., PRAVEENA, P. E. & SINGH, N., 2018. Effects of Pasteurella multocida lipopolysaccharides on bovine leukocytes. Microbial Pathogenesis, 119, 225-232.
- PERINO, L. J. & HUNSAKER, B. D., 1997. A review of bovine respiratory disease vaccine field efficacy. Bovine Practitioner, 31, 59-66.
- PETERS, A. R., 1987. Vaccines for respiratory disease in cattle. Vaccine, 5, 164.
- PETERSON, E. B., STROHBEHN, D. R. & LADD, G. W., 1989. The economic viability of preconditioning for cow-calf producers. Journal of Animal Science, 67, 1687-1697.
- PILLAI, D. K., CHA, E. & MOSIER, D., 2018. Role of the stress-associated chemicals norepinephrine, epinephrine and substance P in dispersal of Mannheimia haemolytica from biofilms. Veterinary Microbiology, 215, 11-17.
- POTGIETER, L. N., 1997. Bovine respiratory tract disease caused by bovine viral diarrhea virus. Veterinary Clinics of North America—Food Animal Practice, 13, 471-481.
- POTGIETER, L. N. D., MCCRACKEN, M. D., HOPKINS, F. M., WALKER, R. D. & GUY, J. S., 1984. Experimental production of bovine respiratory tract disease with bovine viral diarrhea virus. American Journal of Veterinary Research, 45, 1582-1585.
- POTTER, A. A., SCHRYVERS, A. B., OGUNNARIWO, J. A., HUTCHINS, W. A., LO, R. Y. & WATTS, T., 1999. Protective capacity of the Pasteurella haemolytica transferrin-binding proteins TbpA and TbpB in cattle. Microbial Pathogenesis, 27, 197-206.
- PRADO, M. E., DABO, S. M. & CONFER, A. W., 2005. Immunogenicity of iron-regulated outer membrane proteins of Pasteurella multocida A:3 in cattle: molecular characterization of the immunodominant heme acquisition system receptor (HasR) protein. Veterinary Microbiology, 105, 269-280.
- PRIYA, G. B., NAGALEEKAR, V. K., MILTON, A. A. P., SAMINATHAN, M., KUMAR, A., SAHOO, A. R., WANI, S. A., KUMAR, A., GUPTA, S. K., SAHOO, A. P., TIWARI, A. K., AGARWAL, R. K. & GANDHAM, R. K., 2017. Genome wide host gene expression analysis in mice experimentally infected with Pasteurella multocida. PLoS One, 12, e0179420.
- PURDY, C. W., LIVINGSTON, C. W. & FRANK, G. H., 1986. A live Pasteurella haemolytica vaccine efficacy trial. Journal of the American Veterinary Medical Association, 188, 589-591.
- PURDY, C. W., RALEIGH, R. H., COLLINS, J. K., WATTS, J. L. & STRAUS, D. C., 1997. Serotyping and enzyme characterization of Pasteurella haemolytica and Pasteurella multocida isolates recovered from pneumonic lungs of stressed feeder calves. Current Microbiology, 34, 244-249.
- PURDY, C. W., RICHARDS, A. B. & FOSTER, G. S., 1991. Market stress-associated changes in serum complement activity in feeder calves. American Journal of Veterinary Research, 52, 1842-1847.
- QUINN, P. J., 1994. Clinical Veterinary Microbiology. London: Wolfe, 254-258.
- RADOSTITS, O. M. & BLOOD, D. C., 1985. Herd Health—a Textbook of Health and Production Management of Agricultural Animals. Philadelphia: W.B. Saunders.
- RADOSTITS, O. M., BLOOD, D. C. & GAY, C. C., 1994. Veterinary Medicine. 8th edn. London: Baillière-Tindall.
- REHMTULLA, A. J. & THOMSON, R. G., 1981. A review of the lesions in shipping fever of cattle. Canadian Veterinary Journal, 22, 1-8.
- RIBBLE, C. S., 1989. Design considerations in clinical trials. Canadian Veterinary Journal, 30, 292-294.
- RIBBLE, C. S., MEEK, A. H., JIM, G. K. & GUICHON, P. T., 1995. The pattern of fatal fibrinous pneumonia (shipping fever) affecting calves in a large feedlot in Alberta (1985–1988). Canadian Veterinary Journal, 36, 753-757.
- RIBBLE, C. S., MEEK, A. H., SHEWEN, P. E., GUICHON, P. T. & JIM, G. K., 1995. Effect of pretransit mixing on fatal fibrinous pneumonia in calves. Journal of the American Veterinary Medical Association, 207, 616-619.
- RICE, J. A., CARRASCO-MEDINA, L., HODGINS, D. C. & SHEWEN, P. E., 2007. Mannheimia haemolytica and bovine respiratory disease. Animal Health Research Reviews, 8, 117-128.
- RICHESON, J. T., PINEDO, P. J., KEGLEY, E. B., POWELL, J. G., GADBERRY, M. S., BECK, P. A. & FALKENBERG, S. M., 2013. Association of hematologic variables and castration status at the time of arrival at a research facility with the risk of bovine respiratory disease in beef calves. Journal of the American Veterinary Medical Association, 243, 1035-1041.
- RICHESON, J. T., SAMUELSON, K. L. & TOMCZAK, D. J., 2019. Beef species-ruminant nutrition cactus beef symposium: Energy and roughage levels in cattle receiving diets and impacts on health, performance, and immune responses1. Journal of Animal Science, 97, 3596-3604.
- RIMLER, R. B. & RHOADES, K. R., 1987. Serogroup F, a new capsule serogroup of Pasteurella multocida. Journal of Clinical Microbiology, 25, 615-618.
- ROGERS, K. C., MILES, D. G., RENTER, D. G., SEARS, J. E. & WOODRUFF, J. L., 2016. Effects of delayed respiratory viral vaccine and/or inclusion of an immunostimulant on feedlot health, performance, and carcass merits of auction-market derived feeder heifers. Bovine Practitioner, 50, 154-162.
- ROSSI, C. A. S., VANDONI, S. L., BONFANTI, M. & FORBES, A. B., 2010. Effects of arrival medication with gamithromycin on bovine respiratory disease in feedlot cattle in Italy. International Journal of Applied Research in Veterinary Medicine, 8, 87-96.
- ROSSI, C. R. & KIESEL, G. K., 1977. Susceptibility of bovine macrophages and tracheal-ring cultures to bovine viruses. American Journal of Veterinary Research, 38, 1705-1708.
- ROWAN, T. G., SARASOLA, P., SUNDERLAND, S. J., GILES, C. J. & SMITH, D. G., 2004. Efficacy of danofloxacin in the treatment of respiratory disease in European cattle. Veterinary Record, 154, 585-589.
- SANDERSON, M. W., DARGATZ, D. A. & WAGNER, B. A., 2008. Risk factors for initial respiratory disease in United States' feedlots based on producer-collected daily morbidity counts. Canadian Veterinary Journal, 49, 373-378.
- SCHÄKEL, W., 1994. The use of enrofloxacin (BaytrilR) in clinical shipping fever of calves, Bologna, Società Italiana di Buiatria, 619-622.
- SCHIPPER, I. A. & KELLING, C. L., 1971. Shipping fever prophylaxis: comparison of vaccine and antibiotics administered following weaning. Canadian Veterinary Journal, 12, 172-175.
- SCHUMANN, F. J., JANZEN, E. D. & MCKINNON, J. J., 1990. Prophylactic tilmicosin medication of feedlot calves at arrival. Canadian Veterinary Journal, 31, 285-288.
- SCHUNICHT, O. C., BOOKER, C. W., GUICHON, P. T., JIM, G. K., WILDMAN, B. K., HILL, B. W., WARD, T. I. & BAUCK, S. W., 2002. An evaluation of the relative efficacy of a new formulation of oxytetracycline for the treatment of undifferentiated fever in feedlot calves in western Canada. Canadian Veterinary Journal, 43, 940-945.
- SHEWEN, P. E., SHARP, A. & WILKIE, B. N., 1988. Efficacy testing a Pasteurella haemolytica extract vaccine. Veterinary Medicine, 83, 1078-1083.
- SHEWEN, P. E. & WILKIE, B. N., 1982. Cytotoxin of Pasteurella haemolytica acting on bovine leukocytes. Infection and Immunity, 35, 91-94.
- SHEWEN, P. E. & WILKIE, B. N., 1983. Pasteurella haemolytica cytotoxin neutralizing activity in sera from Ontario beef cattle. Canadian Journal of Comparative Medicine, 47, 497-498.
- SHEWEN, P. E. & WILKIE, B. N., 1985. Evidence for the Pasteurella haemolytica cytotoxin as a product of actively growing bacteria. American Journal of Veterinary Research, 46, 1212-1214.
- SHEWEN, P. E. & WILKIE, B. N., 1988. Vaccination of calves with leukotoxic culture supernatant from Pasteurella haemolytica. Canadian Journal of Veterinary Research, 52, 30-36.
- SHIRZAD-ASKI, H. & TABATABAEI, M., 2016. Molecular characterization of Pasteurella multocida isolates obtained from poultry, ruminant, cats and dogs using RAPD and REP-PCR analysis. Molecular Biology Research Communications, 5, 123-132.
- SHIRZAD ASKI, H. & TABATABAEI, M., 2016. Occurrence of virulence-associated genes in Pasteurella multocida isolates obtained from different hosts. Microbial Pathogenesis, 96, 52-57.
- SHOO, M. K., 1989. Experimental bovine pneumonic pasteurellosis: A review. Veterinary Record, 124, 141-144.
- SINGH, K., CONFER, A. W., HOPE, J. C., RIZZI, T., WYCKOFF, J. H. R., WENG, H. Y. & RITCHEY, J. W., 2011a. Cytotoxicity and cytokine production by bovine alveolar macrophages challenged with wild type and leukotoxin-deficient Mannheimia haemolytica. Veterinary Journal, 188, 221-227.
- SINGH, K., CONFER, A. W., STEP, D. L., RIZZI, T., WYCKOFF, J. H. R., WENG, H. Y. & RITCHEY, J. W., 2012. Cytokine expression by pulmonary leukocytes from calves challenged with wild-type and leukotoxin-deficient Mannheimia haemolytica. Veterinary Journal, 192, 112-119.
- SINGH, K., RITCHEY, J. W. & CONFER, A. W., 2011b. Mannheimia haemolytica: bacterial-host interactions in bovine pneumonia. Veterinary Pathology, 48, 338-348.
- SLOCOMBE, R. F., DERKSEN, F. J., ROBINSON, N. E., TRAPP, A., GUPTA, A. & NEWMAN, J. P., 1984. Interactions of cold stress and Pasteurella haemolytica in the pathogenesis of pneumonic pasteurellosis in calves: Method of induction and hematologic and pathologic changes. American Journal of Veterinary Research, 45, 1757-1763.
- SLOCOMBE, R. F., MALARK, J., INGERSOLL, R., DERKSEN, F. J. & ROBINSON, N. E., 1985. Importance of neutrophils in the pathogenesis of acute pneumonic pasteurellosis in calves. American Journal of Veterinary Research, 46, 2253–2258.
- SMITH, C. K., DAVIDSON, J. N. & HENRY, C. W., 1985. Evaluating a live vaccine for Pasteurella haemolytica in dairy calves. Veterinary Medicine, 80, 78-88.
- SMITH, G. R., 1959. Isolation of two types of Pasteurella haemolytica from sheep. Nature, 183, 1132-1133.
- SNEATH, P. H. & STEVENS, M., 1990. Actinobacillus rossii sp. nov., Actinobacillus seminis sp. nov., nom. rev., Pasteurella bettii sp. nov., Pasteurella lymphangitidis sp. nov., Pasteurella mairi sp. nov., and Pasteurella trehalosi sp. nov. International Journal of Systematic and Evolutionary Microbiology, 40, 148-153.
- SNOWDER, G. D., VAN VLECK, L. D., CUNDIFF, L. V. & BENNETT, G. L., 2005. Influence of breed, heterozygosity, and disease incidence on estimates of variance components of respiratory disease in preweaned beef calves. Journal of Animal Science, 83, 1247-1261.
- SNYDER, E. R., CREDILLE, B. C. & HEINS, B. D., 2019. Systematic review and meta-analysis comparing arrival versus delayed vaccination of high-risk beef cattle with 5-way modified-live viral vaccines against BoHV, BRSV, PI3, and BVD types 1 and 2. Bovine Practitioner, 53, 1-7.
- SPORE, T., CORRIGAN, M. E., PARKS, T. R., WEIBERT, C. S., DETRAY, M. L., HOLLENBECK, W. R., WAHL, R. N. & BLASI, D., 2017. Route of Mannheimia haemolytica and Pasteurella multocida vaccine administration does not affect health or performance of receiving heifers. Kansas Agricultural Experiment Station Research Reports, 3, 1-3.
- SQUIRE, P. G., SMILEY, D. W. & CROSKELL, R. B., 1984. Identification and extraction of Pasteurella haemolytica membrane proteins. Infection and Immunity, 45, 667-673.
- SRINAND, S., HSUAN, S. L., YOO, H. S., MAHESWARAN, S. K., AMES, T. R. & WERDIN, R. E., 1996. Comparative evaluation of antibodies induced by commercial Pasteurella haemolytica vaccines using solid phase immunoassays. Veterinary Microbiology, 49, 181-195.
- STEP, D. L., KREHBIEL, C. R., DEPRA, H. A., CRANSTON, J. J., FULTON, R. W., KIRKPATRICK, J. G., GILL, D. R., PAYTON, M. E., MONTELONGO, M. A. & CONFER, A. W., 2008. Effects of commingling beef calves from different sources and weaning protocols during a forty-two-day receiving period on performance and bovine respiratory disease. Journal of Animal Science, 86, 3146-3158.
- STEVENS, P. K. & CZUPRYNSKI, C. J., 1996. Pasteurella haemolytica leukotoxin induces bovine leukocytes to undergo morphologic changes consistent with apoptosis in vitro. Infection and Immunity, 64, 2687- 2694.
- STORZ, J., STINE, L., LIEM, A. & ANDERSON, G. A., 1996. Coronavirus isolation from nasal swab samples in cattle with signs of respiratory tract disease after shipping. Journal of the American Veterinary Medical Association, 208, 1452-1455.
- STRAUS, D. C., JOLLEY, W. L. & PURDY, C. W., 1996. Characterization of neuraminidases produced by various serotypes of Pasteurella multocida. Infection and Immunity, 64, 1446-1449.
- STRAUS, D. C. & PURDY, C. W., 1994. In vivo production of neuraminidase by Pasteurella haemolytica S1in goats after transthoracic challenge. Infection and Immunity, 62, 4675-4678.
- STRAUS, D. C., PURDY, C. W., LOAN, R. W., BRIGGS, R. F. & FRANK, G. H., 1998. In vivo production of neuraminidase by Pasteurella haemolytica in market stressed cattle after natural infection. Current Microbiology, 37, 240-244.
- STROEBEL, C., ALEXANDER, T., WORKENTINE, M. L. & TIMSIT, E., 2018. Effects of transportation to and co-mingling at an auction market on nasopharyngeal and tracheal bacterial communities of recently weaned beef cattle. Veterinary Microbiology, 223, 126-133.
- TAYLOR, J. D., FULTON, R. W., LEHENBAUER, T. W., STEP, D. L. & CONFER, A. W., 2010a. The epidemiology of bovine respiratory disease: What is the evidence for predisposing factors? Canadian Veterinary Journal, 51, 1095-1102.
- TAYLOR, J. D., FULTON, R. W., LEHENBAUER, T. W., STEP, D. L. & CONFER, A. W., 2010b. The epidemiology of bovine respiratory disease: what is the evidence for preventive measures? Canadian Veterinary Journal, 51, 1351-1359.
- THEURER, M. E., WHITE, B. J., ANDERSON, D. E., MIESNER, M. D., MOSIER, D. A., COETZEE, J. F. & AMRINE, D. E., 2013. Effect of transportation during periods of high ambient temperature on physiologic and behavioral indices of beef heifers. American Journal of Veterinary Research, 74, 481-490.
- THOMAS, L. H., 1980. The possible role of respiratory syncytial virus and Pasteurella spp. in calf respiratory disease. Veterinary Record, 107, 304-307.
- THOMSON, R. G., 1984. Pathogenesis of pneumonia in feedlot cattle. In: LOAN, R. W., (ed.). Bovine Respiratory Disease. College Station, Texas: Texas A&M University Press.
- THORLAKSON, B., MARTIN, W. & PETERS, D., 1990. A field trial to evaluate the efficacy of a commercial Pasteurella haemolytica bacterial extract in preventing bovine respiratory disease. Canadian Veterinary Journal, 31, 573-579.
- TIMSIT, E., DENDUKURI, N., SCHILLER, I. & BUCZINSKI, S., 2016. Diagnostic accuracy of clinical illness for bovine respiratory disease (BRD) diagnosis in beef cattle placed in feedlots: A systematic literature review and hierarchical Bayesian latent-class meta-analysis. Preventive Veterinary Medicine, 135, 67-73.
- TIMSIT, E., WORKENTINE, M., VAN DER MEER, F. & ALEXANDER, T., 2018. Distinct bacterial metacommunities inhabit the upper and lower respiratory tracts of healthy feedlot cattle and those diagnosed with bronchopneumonia. Veterinary Microbiology, 221, 105-113.
- VAN DONKERSGOED, J., BERG, J. & HENDRICK, S., 2008. Comparison of florfenicol and tulathromycin for the treatment of undifferentiated fever in Alberta feedlot calves. Veterinary Therapeutics, 9, 275-281.
- VAN DONKERSGOED, J., GUENTHER, C., EVANS, B. N., POTTER, A. A. & HARLAND, R. J., 1995. Effects of various vaccination protocols on passive and active immunity to Pasteurella haemolytica and Haemophilus somnus in beef calves. Canadian Veterinary Journal, 36, 424-429.
- VAN DONKERSGOED, J., POTTER, A. A., MOLLISON, B. & HARLAND, R. J., 1994. The effect of a combined Pasteurella haemolytica and Haemophilus somnus vaccine and a modified-live bovine respiratory syncytial virus vaccine against enzootic pneumonia in young beef calves. Canadian Veterinary Journal, 35, 239-241.
- VAN DONKERSGOED, J., RIBBLE, C. S., BOYER, L. G. & TOWNSEND, H. G., 1993. Epidemiological study of enzootic pneumonia in dairy calves in Saskatchewan. Canadian Journal of Veterinary Research, 57, 247-254.
- VAN DONKERSGOED, J., SCHUMANN, F. J., HARLAND, R. J., POTTER, A. A. & JANZEN, E. D., 1993. The effect of route and dosage of immunization on the serological response to a Pasteurella haemolytica and Haemophilus somnus vaccine in feedlot calves. Canadian Veterinary Journal, 34, 731-735.
- VIRTALA, A. M., MECHOR, G. D., GROHN, Y. T., ERB, H. N. & DUBOVI, E. J., 1996. Epidemiologic and pathologic characteristics of respiratory tract disease in dairy heifers during the first three months of life. Journal of the American Veterinary Medical Association, 208, 2035-2042.
- VOGEL, G. J., LAUDERT, S. B., ZIMMERMANN, A., GUTHRIE, C. A., MECHOR, G. D. & MOORE, G. M., 1998. Effects of tilmicosin on acute undifferentiated respiratory tract disease in newly arrived feedlot cattle. Journal of the American Veterinary Medical Association, 212, 1919-1924.
- WATSON, G. L., SLOCOMBE, R. F., ROBINSON, N. E. & SLEIGHT, S. D., 1995. Enzyme release by bovine neutrophils. American Journal of Veterinary Research, 56, 1055-1061.
- WESSMAN, G. E. & HILKER, G., 1968. Characterization of Pasteurella hemolytica isolated from the respiratory tract of cattle. Canadian Journal of Comparative Medicine, 32, 498-504.
- WHITELEY, L. O., MAHESWARAN, S. K., WEISS, D. J. & AMES, T. R., 1991. Alterations in pulmonary morphology and peripheral coagulation profiles caused by intratracheal inoculation of live and ultraviolet light-killed Pasteurella haemolytica S1 in calves. Veterinary Pathology, 28, 275-285.
- WHITELEY, L. O., MAHESWARAN, S. K., WEISS, D. J., AMES, T. R. & KANNAN, M. S., 1992. Pasteurella haemolytica S1and bovine respiratory disease: pathogenesis. Journal of Veterinary Internal Medicine, 6, 11-22.
- WILKIE, B. N., MARKHAM, R. J. & SHEWEN, P. E., 1980. Response of calves to lung challenge exposure with Pasteurella haemolytica after parenteral or pulmonary immunization. American Journal of Veterinary Research, 41, 1773-1778.
- WILSON, S. H., 1989. Why are meaningful field trials difficult to achieve for bovine respiratory disease vaccines? Canadian Veterinary Journal, 30, 299-302.
- WISEMAN, A., ALLAN, E. M., GIBBS, H. A. & SELMAN, E. I., 1985. Production of transit fever with isolates of Pasteurella haemolytica A1. Bovine Practitioner, 20, 141-143.
- WISSELINK, H. J., CORNELISSEN, J., VAN DER WAL, F. J., KOOI, E. A., KOENE, M. G., BOSSERS, A., SMID, B., DE BREE, F. M. & ANTONIS, A. F. G., 2017. Evaluation of a multiplex real-time PCR for detection of four bacterial agents commonly associated with bovine respiratory disease in bronchoalveolar lavage fluid. BMC Veterinary Research, 13, 221.
- WITTUM, T. E., WOOLLEN, N. E., PERINO, L. J. & LITTLEDIKE, E. T., 1996. Relationships among treatment for respiratory tract disease, pulmonary lesions evident at slaughter, and rate of weight gain in feedlot cattle. Preventive Veterinary Medicine, 209, 814-818.
- YATES, W. D. G., 1982. A review of infectious bovine rhinotracheitis shipping fever pneumonia and viral-bacterial synergism in respiratory disease of cattle. Canadian Journal of Comparative Medicine, 46, 225-263.
- YATES, W. D. G., 1982. A review of infectious rhinotracheitus, shipping fever pneumonia, and viral-bacterial synergism in respiratory diseases of cattle. Canadian Journal of Comparative Medicine, 46, 225–263
- YOUNG, C., 1995. Antimicrobial metaphylaxis for undifferentiated bovine respiratory disease. Compendium on Continuing Education for the Practicing Veterinarian, 17, 133-142.
- ZEINELDIN, M., LOWE, J., DE GODOY, M., MARADIAGA, N., RAMIREZ, C., GHANEM, M., ABD EL-RAOF, Y. & ALDRIDGE, B., 2017. Disparity in the nasopharyngeal microbiota between healthy cattle on feed, at entry processing and with respiratory disease. Veterinary Microbiology, 208, 30-37.
- ZEMAN, D., NEIGER, R., NIETFIELD, J., MISKIMINS, D., LIBAL, M., JOHNSON, D., JANKE, B., GATES, C. & FORBES, K., 1993. Systemic Pasteurella haemolytica infection as a rare sequel to avirulent live Pasteurella haemolytica vaccination in cattle. Journal of Veterinary Diagnostic Investigation, 5, 555-559.
- ZHANG, W., LIU, X., LIU, M., MA, B., XU, L. & WANG, J., 2017. Development of a multiplex PCR for simultaneous detection of Pasteurella multocida, Mannheimia haemolytica and Trueperella pyogenes. Acta Veterinaria Hungarica, 65, 327-339.